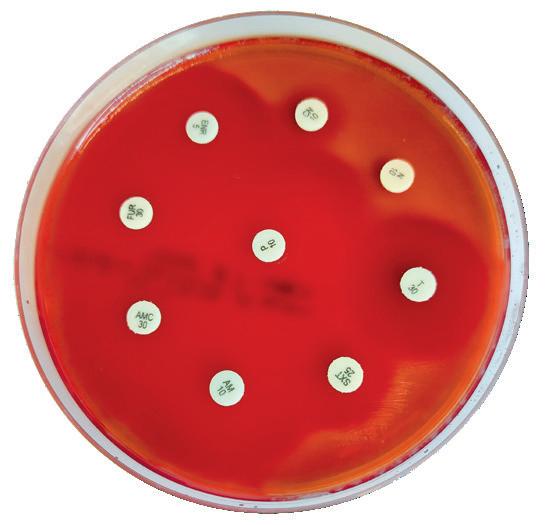

Through its unique formula, TWYDIL® ARTRIDAY participates in the daily maintenance of a good functioning of the joints for a better locomotor comfort. TWYDIL® ARTRIDAY is particularly recommended for horses in training and during a competition period.
Through its unique formula, TWYDIL® ARTRIDAY participates in the daily maintenance of a good functioning of the joints for a better locomotor comfort. TWYDIL® ARTRIDAY is particularly recommended for horses in training and during a competition period.
Through its unique formula, TWYDIL® ARTRIDAY participates in the daily maintenance of a good functioning of the joints for a better locomotor comfort. TWYDIL® ARTRIDAY is particularly recommended for horses in training and during a competition period.


• Unique antidoping contr ol: each batch is officially certified by the LCH (after controls on finished product, urine and blood of a horse having received three times the recommended quantity).
• Unique antidoping contr ol: each batch is officially certified by the LCH (after controls on finished product, urine and blood of a horse having received three times the recommended quantity).
• Unique antidoping contr ol: each batch is officially certified by the LCH (after controls on finished product, urine and blood of a horse having received three times the recommended quantity).
TWYDIL® is used by most of the successful trainers in the world.
PAVESCO AG
TWYDIL® is used by most of the successful trainers in the world.
TWYDIL® is used by most of the successful trainers in the world.
PAVESCO AG
PAVESCO AG
Head Office
Head Office
Head Office
CH-4051 Basel, Switzerland
CH-4051 Basel, Switzerland
CH-4051 Basel, Switzerland
Tel. +41 61 272 23 72
Tel. +41 61 272 23 72
E-mail:info@twydil.com
Tel. +41 61 272 23 72 E-mail:info@twydil.com
E-mail:info@twydil.com
PAVESCO U.K. LTD. 116, High Road Needham, Harleston, Norfolk IP20 9LG
PAVESCO U.K. LTD. 116, High Road Needham, Harleston, Norfolk IP20 9LG
Tel. 01379-85 28 85
Tel. 01379-85 28 85
PAVESCO U.K. LTD. 116, High Road Needham, Harleston, Norfolk IP20 9LG Tel. 01379-85 28 85
e-mail: info@twydil.com
e-mail: info@twydil.com
e-mail: info@twydil.com
Our cover profile trainer, Jérôme Reynier, was (at the time of publication) the fourth leading trainer in France with eighty-seven winners from the 101 horses to have started from his stable this year.

His main base is in the southwest of France, at the Calas training centre, 30km north of Marseille and his runners are an ever increasing presence across the country.
“We have all that we need [in Calas], and the results are proof of that”, recounted Reynier when interviewed by Katherine Ford at Deauville this summer. “I will never abandon Calas because it is a good training centre with a wonderful climate, and it allows us to create a very progressive programme for the horses. We like to run our horses as much as possible rather than over-train them, so we provide a lot of runners for the PMU. Our owners want to see their horses at the races, so as soon as the horse is ready, whatever his level, I find a race for him. I find the French programme clear and simple, with opportunities for all categories.”
Indeed, looking at the average number of runs per horse in France this year, Reynier’s name is near the top of the list with an average of five per horse in his care.


“The French system makes this possible if you have a healthy horse who can run regularly”, says Reynier. “The French way of constructing a career is with a horse that might be just 80 percent ready for his debut and he will progress as he races. So, we can think of the long term rather than the short term. As long as we can keep our system in France with the PMU and decent prize money, we are privileged. But a whole generation of punters is on the way out, and I don’t see many young people betting on racing, so I often feel pessimistic”.

But what about the racecourse looking to offer better value for those who bet on the sport?
For this opinion we turn to Dermot Cantillon who talks to Daragh Ó Conchúir for a wide ranging interview that covers everything from the business of breeding and raising horses to the running of his beloved Naas racecourse.
Cantillon believes that the betting tax should be limited to winnings for off-course bookies but be increased to three percent. This would lead to a likely increase in funding for racing, he argues. It would also go some way to arresting the decline of the on-course betting ring that used to be central to the race-day experience.
“When I was on the board at Naas first around 25 years ago, a very good race meeting could turn over a million pounds on-track. Now we’re looking at 150 (thousand). There’s a crisis. We need to do something radical about the crisis.”


Lissa Oliver talks to Eve Johnson Houghton about Streets Of Gold and the journey that got them to the winners circle for the 2022 renewal of the Tattersalls Ireland Super Sales Stakes.
Katherine Ford profiles the ‘provincial based’ trainer who has cemented himself as one of the leading trainers in France.

Peter W. Physick-Sheard shares his research on the possible links with EIPH and other conditions.
Kerrie Kavanagh writes about the use of Probiotics as an alternative to Antibiotics - to reduce resistance in the gut.
Daragh Ó Conchúir interviews Dermot Cantillon. Covering Cantillon’s passion and views on racing and what it takes to breed winners and run a racecourse.
Annie Lambert explains what the Horseracing Integrity and Safety Act (HISA) racing rules and regulations will mean for European horsemen travelling to the United States this autumn.
to download our current digital editions and access back issues of both European and North American Trainer.

Rhi Lee-Jones reports from the fifth Horseracing Industry annual conference held at Newbury Racecourse.

Know your structures - Peter Milner investigates synovial infections and the factors which can influence the outcome for the horse.
Paull Khan explores; racing in Switzerland, reports from the first Pony Racing Association meeting, unveils the new Spanish Beach Race Festival and looks ahead to the return of Morocco’s international thoroughbred race day.





Sub-Editor
Jana CavalierDesign/Production
Damian Browning
Advert Production
Lauren Godfray
Circulation/Website
Helen MacPhail / Lauren GodfrayAdvertising Sales
Giles Anderson
Cover Photograph
APRH / Clementine Veret Trainer magazine is published by Anderson & Co Publishing Ltd.
This magazine is distributed for free to all ETF members. Editorial views expressed are not necessarily those of the ETF. Additional copies can be purchased for £8.95 (ex P&P). No part of this publication may be reproduced in any format without the prior written permission of the publisher.
Printed in the European Union
For all editorial and advertising queries please contact: Anderson & Co. Publishing
Tel: +44 (0) 1380 816777
Fax: +44 (0) 1380 816778 email: info@trainermagazine.com www.trainermagazine.com
Katherine Ford After completing a degree in languages and the BHA Graduate Development programme, she moved to France for a season with the International Racing Bureau’s Paris office. She then joined French racing channel Equidia’s international department which has taken to racecourses around the world. She now splits her time between Equidia, Sky Sports Racing’s French coverage and freelance writing.
Kerrie Kavanagh is a PhD candidate (through University Of Limerick) where her research focuses on studying the equine microbiome and developing an equine autogenous probiotic. Her work as a Senior Microbiologist at the Irish Equine Centre involves running the Microbiology lab dealing with outbreaks such as Strangles, reproductive venereal pathogens, enteric investigations, parasitology, epidemiology, water & environmental monitoring & disinfectant efficacy trials for equine use.
Paull Khan, PhD. is an international horseracing consultant. He is secretary-general of the European & Mediterranean Horseracing Federation and technical advisor for Europe to the International Federation of Horseracing Authorities. His other clients include the British Horseracing Board. Previously, Dr Khan held many senior roles at Weatherbys, including banking director and racing director.
Annie Lambert is a photojournalist based in Temecula, California. She grew up enjoying many facets of the equine industry with her veterinarian father, Dr. Willard D. Ommert, and mother, Pat North Ommert, who is an inductee of the National Cowgirl Hall of Fame. Annie has been involved in many aspects of the Thoroughbred racing industry, rode hunters and jumpers as well as reined cow horses.
Rhi Lee-Jones is head of communications and events at the Racing Foundation and organises the annual Horseracing Industry Conference, which sees delegates from across British racing and other global racing jurisdictions attend a day of learning, challenge and debate. Rhi leads the Racing Foundation's communications and advises the Foundation's beneficiaries on the development of their own strategies. An experienced communications executive, she previously worked as a horse racing journalist for the BBC and as an equestrian sport presenter. She is a keen rider and events on her former chaser Bob Will.
Dr Peter Milner is Senior Lecturer in Equine Orthopaedics at Liverpool University (UK). His role involves lameness investigation and orthopaedic surgery and he is interested in advanced diagnostic imaging modalities, particularly MRI.
Daragh Ó Conchúir is a native of Rinn Ó gCuanach, Co Waterford, and a freelance media professional with more than 30 years’ experience of writing and broadcasting in sport, covering a multitude of disciplines and roles for a variety of national and regional organisations. He is an author of four books, nominee as HWPA Racing Writer of the Year (for Irish and UK racing writers) and reporter for TG4’s acclaimed Rásaí Beo racing coverage.
Lissa Oliver lives in Co. Kildare, Ireland and is a regular contributor to The Irish Field and the Australian magazine, Racetrack. Lissa is also the author of several collections of short stories and two novels
Dr Peter W. Physick-Sheard describes himself as a clinician, not a researcher, though since health issues caused him to move out of the clinic and deemphasise hands-on engagement in equine clinical cardiology his time has primarily been taken up in teaching and research. His main interests are cardiovascular medicine in the performance horse, health management and industry studies with particular emphasis on epidemiologic investigations, always with a performance twist. He is a graduate of Bristol University School Of Veterinary Science and came to the University of Guelph, Canada, shortly after graduating. The atmosphere must be conducive because he only went for a year and is still there! His greatest motivators continue to be the horse and seeing young people succeed in their careers.




Cavalor ArtiTec gives our equine athletes what they need during periods of intense work. Cavalor ArtiTec is the result of 7 years of scientific research (in collaboration with UGent) on optimum nutritional supplements for healthy tendons and joints in top-class sport horses. The resulting specific combination and balance of substances not only promotes healthy tendons and joints, it also offers ideal protection against damage caused by strain.




The TopSpec Trainer of the Quarter award has been won by Eve Johnson Houghton. Johnson Houghton and her team will receive £1,000 worth of TopSpec feed, supplements and additives as well as a consultation with one of their senior nutritionists.
 Lissa Oliver Healy Racing
Lissa Oliver Healy Racing
The Tattersalls Ireland Super Auction Sale Stakes during Irish Champions weekend earned Streets Of Gold €147,500, which isn’t bad going for a colt picked up at the Tattersalls Ireland September Yearling Sale last year for just £27,000; it was held in Newmarket due to COVID restrictions. At time of writing, he is currently unbeaten in four starts, yet further reason to award Trainer of the Quarter to Eve Johnson Houghton.
Johnson Houghton trains at the historic Woodway Stables on the Berkshire Downs, with 200 acres of private turf downland gallops and a seven-furlong all-weather gallop at her disposal. Sixteen Gp. 1 winners have been sent out from Woodway, Johnson Houghton following in the footsteps of her father Fulke and grandparents Helen and Gordon at the idyllic yard. She is fast-carving out her own place in history, and a quality group of two-year-olds bode
well for next season, with Streets Of Gold the obvious flagbearer.
“When I bought him, he was a first foal lacking an inch or two, but he was a great walker; and he reminded me a lot of Chipotle, who was by the same sire,”

Johnson Houghton reveals of the Havana Grey colt. Chipotle, of course, was last year’s bargain buy who came very good for the Woodway team. “He had a great page, and I can’t believe the price I got him for.
“I put two owners together, Jonny Allison and Gary Stevens, and they are thrilled with him. He runs in alternate colours—one race Jonny’s, the next Gary’s— so both have had equal success, which is really good.
“He didn’t show us much at home. He’s the type of horse who just gets up, does his job and goes back to sleep! He’s not flashy in any way. So I found a fairly poor race for his debut and he fell out of the stalls, and I thought that was his chance gone. But he motored through for a four-length win, and I thought then that was a bit exciting. Next time out at Newmarket he beat a subsequent Group-winning filly, and at York, he was a little motorbike!”
Johnson Houghton describes Streets Of Gold as the easiest horse to train. “He will drop his shoulder occasionally, but

there’s never any malice; and he is just very straightforward.” At time of writing, she has just made an entry for him in the Irish 2000 Guineas and will think about one of the trials for him for next year.
“The EBF Restricted Final at York will probably be his next start and final race of the season. The prize money for that is more than he’ll get in a Listed. Then that’s it for the year. His pedigree suggests he’s good enough to run in a Guineas, and so far he’s done nothing to say he won’t be.
“For the team, it means the world to have horses like this. We have a great
team of staff who buy into the team ethic and all get it; they all get on together and are all pulling in the same direction, and they are having a ball.”
Johnson Houghton also has a nice filly in the shape of Rage Of Bamby, who could well extend her unbeaten run to three in the Gp. 2 Rockfel Stakes at Newmarket, and as she points out, “The quality of our two-year-olds is upped year-on-year. I buy with Anthony Bromley of Highflyer, and I think we’re getting it right. We have a horse to go to war with next year, and I am very grateful to my team.”
THE QUALITY OF OUR TWO-YEAR-OLDS IS UPPED YEAR-ON-YEAR. I BUY WITH ANTHONY BROMLEY OF HIGHFLYER, AND I THINK WE’RE GETTING IT RIGHT.”
EVE JOHNSON HOUGHTON

Take a look at the French trainers’ standings in September, and hot on the heels of the Classic powerhouses of Rouget, Fabre and Graffard in fourth place was Jérôme Reynier. Based in his native Marseille, still a couple of years shy of his 40th birthday, the discreet yet determined professional has climbed step by step to racing’s top table, and his ascension is far from over.
Imet Reynier at Deauville during the August meeting and interrupted his breakfast with half a dozen staff. “We have a family atmosphere and a good relationship. I’m not a difficult boss, but if there are decisions to be made, that’s my job. I don’t want anyone else to take initiatives without consulting me first. That’s why I’m always available in case there’s a problem,” Reynier admits.
What is striking with Reynier is an attention to detail, whether that be in the organisation of his training regime, his assiduous desire to answer any queries from any quarters, or his true passion and almost encyclopaedic knowledge of bloodstock and racing. Going back to the origins of his love of racing, he explains, “I caught the virus from my father who was an architect but passionate about racing and breeding. I was born in 1985, and that was the year that he bred his first horse, called Shaindy.”
Reynier goes on to recount in great detail the destiny of Shaindy, who was bought back as a yearling and ended up Group-placed as a juvenile and winner of the then Listed Prix Djebel. It is easy to forget from the vividness of the description that at the time he was still in nappies and has no direct memories of the time. “It was magical, for a first homebred, carrying my grandfather’s colours. That caused a snowball effect with my father who bought more mares. He was lucky, but then you make your own luck.”
Just a few years later Reynier’s father sold all his burgeoning thoroughbred interests when his son was still too small to remember, in order to devote more time to his wife and family.
However, the marriage broke down and his son remembers, “My parents separated when I was 12, and I went to live with my father who took me to Deauville sales to see if I took to the bloodstock world. It was all new to me, but I loved it and thought of nothing else from then on.
“At school, I put sales catalogues inside my textbooks; so during lessons I was engrossed in the pedigree pages. I had never touched a horse in my life—my experience all came from books as there wasn’t even [French racing channel] Equidia at the time.”
At 15 years old, Jérôme Reynier had his first handson experience during a summer at Alain Brandebourger’s Haras de Chartreux, and the following summer his father sent him to Newmarket to learn English. “I spent two months with David Shekells at Old Mill Stud. He had two yearlings for Deauville sales, but I was only tiny and not strong enough to hold a yearling weighing 400kg. They were both monsters—a Nashwan and an Unfuwain—so my job for two months was to walk behind them to keep them moving forward.
“Then during the journey from Newmarket to Deauville, I had to travel in the back of the horsebox at their heads all the way to stop them from fighting. It was a real test of my enthusiasm!”

Jérôme passed the test with flying colours, and his enthusiasm remained intact, more so than his academic career, which suffered from his obsession with thoroughbreds. “I failed my Bac [baccalauréat], and things weren’t easy then as I had no qualifications, contacts or references. When I went to the races at Deauville, I didn’t have access to any of the reserved areas; I saw racing as a very closed environment. For me, it was unattainable. During that summer, I worked at the Forien’s Haras de Montaigu to prepare the yearlings. After that, I applied to do a season at Coolmore, and they took me on from January to June in 2005; so I went to Ireland and passed my Bac as an external candidate.”

Jérôme Reynier has stars in his eyes as he remembers his stint at Coolmore. “I worked in one of the small yards with barren or maiden mares, so there were no foals but some amazing pedigrees, and we took them to stallions like Sadler’s Wells, Galileo and Montjeu. I got to see the stallions and how the system worked. I was always more interested in the pedigrees and breeding aspect than the racing in the afternoon.”
The Irish National Stud course followed in 2006 and while there, the determined and precocious Jérôme applied for and was accepted onto the Darley Flying Start programme. “I didn’t waste a minute!” he remembers. “In 2008 I was 22 years old and found myself with qualifications from the Irish National Stud and Darley Flying Start. The problem was that I was overqualified for my age. I needed work, but everyone considered that I was too young to take on the jobs in the breeding industry that I was qualified for. At the same time, my father fell ill so I
went back to Marseille and as nobody would employ me, I set up my own business as a bloodstock agent. But I soon realised it was very difficult to earn a living without a large volume of trade. I knew a few people, but I didn’t have a network of clients. I was young and based in Marseille, so I didn’t tick the boxes…”
It was therefore by default that Reynier began his successful training career, initially as a private trainer for the Ecurie Camacho Courses. “I was employed to train around 15 horses for them at Marseille, and in two years we had 38 winners and €800,000 in earnings with modest horses. It was a great way to start off, but after two years, I wanted my independence.”



From four horses at the outset in March 2013, the ambitious professional soon made himself noticed and his stable grew. “I was getting good results, including in the Parisian region where I could find favourable entries and make a name for myself, rather than focusing on local races at Marseille. I’ve always tried to look beyond my immediate horizon. I had horses of a limited quality, but my passion was to find winnable races. I was back to what I loved—really hands on, mucking out in the morning, going to the track, driving the horses to races myself. I wouldn’t hesitate to make a long journey for a made-to-measure entry. I think that was the best period in my career as a trainer.”
Reynier was hit hard by the untimely death of his father in November 2014 and doubled down to bury his grief in work, “to make him proud from where he is now.”
He was satisfied with his 40-capacity stable but in 2018 received a career-changing offer from powerful local owner JeanClaude Seroul, whose orange and grey colours were a familiar sight in Marseille. They are now known far beyond, thanks notably to the exploits of prolific top-level winners Skalleti and Marianafoot.
Reynier took on the job as private trainer to Seroul’s 50-55 strong string, based just across the road from his own yard at the Calas training centre, 30km north of Marseille, “Mr Seroul has his own stable, his own horses and his own staff; it didn’t affect my own structure. They are two separate operations, and the strings don’t go out at the same time; so instead of having four lots with 30 riders in each, I have eight lots with 15 riders each time. It’s much more manageable as I like to give each rider precise instructions for including the exact position of every horse in each lot. All the details are indicated on the list, which is sent out the previous evening, and that organisation now allows me to delegate more; and for instance to spend the month here in Deauville where we have an allocation of 14 boxes and a rotation of horses. If we win six races here and a few places, it will be a good result.”


That August target was achieved with the highlight being a Listed victory for the Seroul-owned filly, Rose Premium.
The conversation moves back to Calas, described by Reynier as a “perfect” facility with a main 3km round track, which gives the opportunity to work left- or right-handed depending upon the day. It also offers an incline for interval training, as well as turf, sand and jumps schooling tracks. “We have all that we need, and the results are proof of that. I will never abandon Calas because it is a good training centre with a wonderful climate, and it allows us to create a very progressive programme for the horses. We all—Christophe Escuder, Fabrice Vermeulen and myself—like to run our horses as much as possible rather than over-train them, so we provide a lot of runners for the PMU. Our owners want to see their horses at the races, so as soon as the horse is ready, whatever his level, I find a race for him. I find the French programme clear and simple, with opportunities for all categories.”
Marseille was rocked in late 2021 as dawn raids saw three members of the Rossi family among several professionals taken into police custody under suspicion of the use of forbidden substances and conspiracy to defraud and fix races. Frederic, Cédric and Charley, who were responsible for around 150 horses at Calas, are currently suspended from training and under police investigation. Reynier comments, “It saddened me because I know Cedric and Charley (Rossi) well, and I am sure that they

Since using B-Complete even the fussiest of eaters have licked their bowls clean. The summer jumpers have bounced out of their races very well and eaten up straight after racing. I feel it really helps their energy levels and I’m looking forward to using it through the winter. It will come into it’s own when the horses need the extra energy during the bad weather and heavy winter ground.

“
Paul Nicholls
are not cheats. It’s been a tough time for the region to be in the spotlight for negative reasons, and there is also the risk that if we don’t generate enough runners for turnover on the PMU, they will reduce the number of races at our tracks.”
The city’s best racecourse, seaside Marseille-Borély, is already under threat of closure and Reynier adds, “The lease has been extended until 2024. It’s perfectly situated for development, but it will be a disaster if it is lost; so that’s why it is important to keep an open mind geographically. I wouldn’t exclude creating a small satellite yard in Chantilly to start with to avoid too much travelling for some of the horses. Then why not extend the Chantilly stable to have two bases… But it is certain that the future lies in Paris, or maybe abroad.”
Jérôme Reynier has always had the opposite of a blinkered approach and loves to see a well-made plan come to fruition, as his first stable star Royal Julius, winner of the inaugural Bahrain International Trophy, demonstrates. “When Bahrain created the new international race, the prize money was very generous. And the conditions were optimal for Royal Julius, who was a true right-hander who loved a fast surface and ten furlongs, so I set out to prepare and qualify him for that race. He needed to keep a high rating, so I sent him to Italy where it was easy for him to do well in Stakes company; whereas if I’d run him in a Gp. 3 in France and he’d finished fifth, his rating would have dropped and I would never have been invited there or to Qatar. He was a great horse for the stable, as was Master Spirit who was a “second hand” horse we received; and from being a handicapper, we managed to take second place in the Grand Prix de Deauville
with him. I’ve been lucky to train some good horses, but it’s important to take good care of them to age well.”
More recently, flag bearers Skalleti and Marianafoot have rewarded the patience and skill of their handler, along with Thunder Drum who joined Reynier for owner Lady Bamford. “It was particularly satisfying for me to receive beautifully bred horses for Lady Bamford and exceptional to win the Prix du Royaumont (Gp. 3) last year on Jockey-Club day with Thunder Drum, who couldn’t win a maiden in England as a juvenile. We had intended to run her in the Italian Oaks that weekend but made a last-minute change of plan due to a modest field and rain in Chantilly; and it worked perfectly! As for Skalleti and Marianafoot, they both had their best seasons last year at six years old, which is amazing. In fact, I was the leading French trainer on Gp. 1 wins, with the three victories of that pair. Cédric Rossi and André Fabre had two each!”
“We don’t have a star this year, but a lot of horses are earning their keep and that keeps the stable going. Take the example of Happy Harry, a son of Zarak that we claimed in January; in six months, he has earned €70,000 (the gelding boosted his earnings by a further €14,000 in prize money and owners’ premiums for a handicap win days after our interview). If I have 50 Happy Harrys, I’m happy! The French system makes this possible if you have a healthy horse who can run regularly. In England, if you have a decent horse, you either try and win some good races or you try the commercial route, win on the debut and then sell it on. It’s impossible to earn money with prize money in England, and I couldn’t train there. It’s a different policy. The French way of constructing a career is with a horse that might be just 80 percent ready for his debut and he will progress as he races. So, we can think of the long term rather than the short term. As long as we can keep our system in France with the PMU and decent prize money, we are privileged. We are the best country for racing in Europe or maybe in the world, but a whole generation of punters is on the way out, and I don’t see many young people betting on racing, so I often feel pessimistic.”

Despite his concerns, Jérôme Reynier is, as always, aware of upcoming opportunities and a changing of the guard, which may enable him to move even further up racing’s top table. “There is a whole older generation of trainers in Chantilly who are on the way out, so there will be opportunities. The new trainers who are there now and setting up soon will create a new dynamism. Maybe I will be a part of it and maybe I won’t…”
One thing is certain, whatever Jérôme Reynier does or doesn’t become a part of will depend upon a carefully constructed plan, leaving little to chance and attracting more good luck his way.






World's Your Oyster, a three-year-old thoroughbred mare, presented at the veterinary hospital for clinical examination. She won her maiden start as a two-year-old and placed once in two subsequent starts. After training well as a three-year-old, she failed to finish her first start, easing at the top of the stretch, and was observed to fade abruptly during training. Some irregularity was suspected in heart rhythm after exercise. Thorough clinical examination, blood work, ultrasound of the heart and an ECG during rest and workout revealed nothing unusual.
Returning to training, Oyster placed in six of her subsequent eight starts, winning the last two. She subsequently died suddenly during early training as a four-year-old. At post-mortem, diagnoses of pulmonary haemorrhage and exercise-induced pulmonary haemorrhage were established—a very frustrating and unfortunate outcome.
Across the racing world, a case like this probably occurs daily. Anything that can limit a horse's ability to express its genetic potential is a major source of anxiety when training. The possibility of injury and lameness is the greatest concern, but a close second is respiratory disease, with bleeding from the lungs

(most often referred to as exercise induced pulmonary [lung] haemorrhage or EIPH) being high on the list.
EIPH is thought to occur in as many as 85 percent of racehorses, and may initially be very mild without obvious clinical consequences. In some cases it can be associated with haemorrhage of sufficient severity for blood to appear at the nostrils, even at first occurrence. In many racing jurisdictions this is a potentially career-ending problem. In these horses, an impact on performance is unquestionable. Bleeding from the lungs is the reason for the existence of ‘Lasix programs,’ involving pre-race administration of a medication considered to reduce haemorrhage. Such programs are controversial—the justifications for their existence ranging from addressing welfare concerns for the horse to dealing with the performance impacts.
Much less frequently encountered is heavy exercise-associated bleeding from the nostrils (referred to as epistaxis), which can sometimes be accompanied by sudden death, during or shortly after exercise. Some horses bleed heavily internally and die without blood appearing at the nostrils. Haemorrhage may only become obvious when the horse is lying on its side, or not until post-mortem. Affected animals do not necessarily have
Dr Peter W. Physick-Sheard, BVSc, FRCVS, explores preliminary research and hypotheses, being conducted by the University of Guelph, to see if there is a possibility that these conditions are linked and what this could mean for future management and training of thoroughbreds.
any history of EIPH, either clinically or sub-clinically. There is an additional group of rare cases in which a horse simply dies suddenly, most often very soon after work and even after a winning performance, and in which little to nothing clearly explains the cause on post-mortem. This is despite the fact most racing jurisdictions study sudden death cases very closely.

EIPH is diagnosed most often by bronchoscopy—passing an endoscope into the lung after work and taking a look. In suspected but mild cases, there may not be sufficient haemorrhage to be visible, and a procedure called a bronchoalveolar lavage is performed. The airways are rinsed and fluid is collected and examined microscopically to identify signs of bleeding. Scoping to confirm diagnosis is usually a minimum requirement before a horse can be placed on a Lasix program.
At the University of Guelph, we are working on the hypothesis that most often they are not different—that it’s degrees of the same condition, or closely related conditions perhaps with a
common underlying cause. We see varying clinical signs as being essentially a reflection of severity and speed of onset of underlying problems.
Causes in individual cases may reflect multiple factors, so coming at the issues from several different directions, as is the case with the range of ongoing studies, is a good way to go so long as study subjects and cases are comparable and thoroughly documented. However, starting from the hypothesis that these may all represent basically the same clinical condition, we are approaching the problem from a clinical perspective, which is that cardiac dysfunction is the common cause.
Numerous cardiac disorders and cellular mechanisms have the potential to contribute to transient or complete pump (heart) failure. However, identifying them as potential disease candidates does not specifically identify the role they may have played, if any, in a case of heart failure and in lung haemorrhage; it only means that they are potential primary underlying triggers. It isn't possible for us to be right there when a haemorrhage event occurs, so almost invariably we are left looking at the outcome—the event of interest has passed. These concerns influence the approach we are taking.
The superlative performance ability of a horse depends on many physical factors:
• Huge ventilatory (ability to move air) and gas exchange capacity
• Body structure including limb length and design – allows it to cover ground rapidly with a long stride
• Metabolic adaptations – supports a high rate of energy production by burning oxygen, tolerance of severe metabolic disruptions toward the end of race-intensity effort
• High cardiovascular capacity – allows the average horse to pump roughly a brimming bathtub of blood every minute
At race intensity effort, these mechanisms, and more, have to work in coordination to support performance. There is likely not much reserve left—two furlongs (400m) from the winning post—even in the best of horses. There are many wild cards, from how the horse is feeling on race day to how the race plays out; and in all horses there will be a ceiling to performance. That ceiling—the factor limiting performance—may differ from horse to horse and even from day to day. There’s no guarantee that in any particular competition circumstances will allow the horse to perform within its own limitations. One of these factors involves the left side of the heart, from which blood is driven around the body to the muscles.


The cardiovascular system of the horse exhibits features that help sustain a high cardiac output at peak effort. The feature of concern here is the high exercise pressure in the circulation from the right ventricle, through the lungs to the left ventricle. At intense effort and high heart rates, there is very little time available to fill the left ventricle—sometimes as little as 1/10 of a second; and if the chamber cannot fill properly, it cannot empty properly and cardiac output will fall. The circumstances
ABOVE: At intense effort and high heart rates, there is little time to fill the left ventricle—sometimes as little as 1/10 of a second; and if the chamber cannot fill properly, it cannot empty properly and cardiac output will fall.
required to achieve adequate filling include the readiness of the chamber to relax to accept blood—its ‘stiffness.’ Chamber stiffness increases greatly at exercise, and this stiffened chamber must relax rapidly in order to fill. That relaxation seems not to be sufficient on its own in the horse at high heart rates. Increased filling pressure from the circulation draining the lungs is also required. But there is a weak point: the pulmonary capillaries. These are tiny vessels conducting blood across the lungs from the pulmonary artery to the pulmonary veins. During this transit, all the gas exchange needed to support exercise takes place. The physiology of other species tells us that the trained lung circulation achieves maximum flow (equivalent to cardiac output) by reducing resistance in those small vessels. This process effectively increases lung blood flow reserve by, among other things, dilating small vessels. Effectively, resistance to the flow of blood through the lungs is minimised. We know this occurs in horses as it does in other species; yet in the horse, blood pressure in the lungs still increases dramatically at exercise.
If this increase is not the result of resistance in the small vessels, it must reflect something else, and that appears to be resistance to flow into the left chamber. This means the entire lung circulation is exposed to the same pressures, including the thin-walled capillaries. Capillaries normally work at quite low pressure, but in the exercising horse, they must tolerate very high pressures. They have thin walls and little between them, and the air exchange sacs in the lung. This makes them vulnerable. It's not surprising they sometimes rupture, resulting in lung haemorrhage.
Recent studies identified changes in the structure of small veins through which the blood flows from the capillaries and on toward the left chamber. This was suspected to be a pathology and part of the long-term consequences of EIPH, or perhaps even part of the cause as the changes were first identified in EIPH cases. It could be, however, that remodelling is a normal response to the very high blood flow through the lungs—a way of increasing lung flow reserve, which is an important determinant of maximum rate of aerobic working.
The more lung flow reserve, the more cardiac output and the more aerobic work an animal can perform. The same vein changes have been observed in non-racing horses and horses without any history or signs of bleeding. They may even be an indication that everything is proceeding as required and a predictable consequence of intense aerobic training. On the other hand, they may be an indication in some horses that the
rate of exercise blood flow through their lungs is a little more than they can tolerate, necessitating some restructuring. We have lots to learn on this point.
If the capacity to accommodate blood flow through the lungs is critical, and limiting, then anything that further compromises this process is likely to be of major importance. It starts to sound very much as though the horse has a design problem, but we shouldn't rush to judgement. Horses were probably not designed for the very intense and sustained effort we ask of them in a race. Real-world situations that would have driven their evolution would have required a sprint performance (to avoid ambush predators such as lions) or a prolonged slower-paced performance to evade predators such as wolves, with only the unlucky victim being pushed to the limit and not the entire herd.
There is another important element to this story. High pressures in the capillaries in the lung will be associated with significant movement of fluid from the capillaries into lung tissue spaces. This movement in fact happens continuously at all levels of effort and throughout the body—it's a normal process. It's the reason the skin on your ankles ‘sticks’ to the underlying structures when you are standing for a long time. So long as you keep moving a little, the lymphatic system will draw away the fluid.
In a diseased lung, tissue fluid accumulation is referred to as pulmonary oedema, and its presence or absence has often been used to help characterise lung pathologies. The lung lymphatic system can be overwhelmed when tissue fluid is produced very rapidly. When a horse experiences sudden heart failure, such as when the supporting structures of a critical valve fail, one result is massive overproduction of lung tissue fluid and appearance of copious amounts of bloody fluid from the nostrils.


The increase in capillary pressure under these conditions is as great as at exercise, but the horse is at rest. So why is there no bloody fluid in the average, normal horse after a race? It’s because this system operates very efficiently at the high respiratory rates found during work: tissue fluid is pumped back into the circulation, and fluid does not accumulate. The fluid is pumped out as quickly as it is formed. An animal’s level of physical activity at the time problems develop can therefore make a profound difference to the clinical signs seen and to the pathology.

LEFT: An ECG from a racehorse shortly after crossing the finishing line. In this case the horse is exhibiting serious disturbances of heart rhythm. Interval between beats varies constantly and even when interval appears stable, the conformation of the waveforms is abnormal and variable. Waveform height also varies constantly. This horse returned to normal heart rhythm spontaneously as heart rate fell and continued to race successfully for the following year. There was no opportunity to test this horse for bleeding. However, no clinical signs were observed and had the horse not been undergoing research observation, the arrhythmia would not have been detected. The significance of these variations in the horse remains poorly understood. Similar variations under exercise conditions in humans would be regarded as pathological. Image Dr Peter Physick-Sheard, University of Guelph.

If filling the left ventricle and the ability of the lungs to accommodate high flow at exercise are limiting factors, surely this affects all horses. So why do we see such a wide range of clinical pictures, from normal to subclinical haemorrhage to sudden death?
Variation in contributing factors such as type of horse, type and intensity of work, sudden and unanticipated changes in work intensity, level of training in relation to work and the presence of disease states are all variables that could influence when and how clinical signs are seen, but there are other considerations.
Although we talk about heart rate as a fairly stable event, there is in fact quite a lot of variation from beat to beat. This is often referred to as heart rate variability. There has been a lot of work performed on the magnitude of this variability at rest and in response to various short-term disturbances and at light exercise in the horse, but not a lot at maximal exercise. Sustained heart rate can be very high in a strenuously working horse, with beats seeming to follow each other in a very consistent manner, but there is in fact still variation.
Some of this variation is normal and reflects the influence of factors such as respiration. However, other variations in rate can reflect changes in heart rhythm. Still other variations may not seem to change rhythm at all but may instead reflect the way electrical signals are being conducted through the heart.
These may be evident from the ECG but would not appear abnormal on a heart rate monitor or when listening. These variations, whether physiologic (normal) or a reflection of abnormal function, will have a presently, poorly understood influence on blood flow through the lungs and heart—and on cardiac filling. Influences may be minimal at low rates, but what happens at a heart rate over 200 and in an animal working at the limits of its capacity?
Normal electrical activation of the heart follows a pattern that results in an orderly sequence of heart muscle contraction, and that provides optimal emptying of the ventricles. Chamber relaxation complements this process.
An abnormal beat or abnormal interval can compromise filling and/or emptying of the left ventricle, leaving more blood to be discharged in the next cycle and back up through the lungs, raising pulmonary venous pressure. A sequence of abnormal beats can lead to a progressive backup of blood, and there may not be the capacity to hold it—even for one quarter of a second, a whole cardiac cycle at 240 beats per minute.
For a horse that has a history of bleeding and happens to be already functioning at a very marginal level, even minor disturbances in heart rhythm might therefore have an impact.

Horses with airway disease or upper airway obstructions, such as roarers, might find themselves in a similar position. An animal that has not bled previously might bleed a little, one that has a history of bleeding may start again, or a chronic bleeder may worsen.
Relatively minor disturbances in cardiac function, therefore, might contribute to or even cause EIPH. If a horse is in relatively tough company or runs a hard race, this may also contribute to the onset or worsening of problems. Simply put, it's never a level playing field if you are running on the edge.
It has been suspected for many years that cases of horses dying suddenly at exercise represent sudden-onset cardiac dysfunction— most likely a rhythm disturbance. If the rhythm is disturbed, the closely linked and carefully orchestrated sequence of events that leads to filling of the left ventricle is also disturbed. A disturbance in cardiac electrical conduction would have a similar effect, such as one causing the two sides of the heart to fall out of step, even though the rhythm of the heart may seem normal.
The cases of horses that bleed profusely at exercise and even those that die suddenly without any post-mortem findings can be seen to follow naturally from this chain of events. If the changes in heart rhythm or conduction are sufficient, in some cases to cause massive pulmonary haemorrhage, they may be sufficient in other cases to cause collapse and death even before the horse has time to exhibit epistaxis or even clear evidence of bleeding into the lungs.


Evaluate your horses’ fitness and closely monitor the training workloadPrevent the injury risk thanks to continued follow-up
Quantify your horses’ speed abilities



Thanks to Arioneo, we noticed that Skaletti is a metronome. He always has the same stride length and recovery data. As the months and years pass, he remains the same Skalleti, which gives us confidence to return to racing. You can really see it in the data: we prepare the horse with great regularity, and he manages to give us very similar data. He reappears after three or four months of inactivity to be the Skalleti we know. It is very useful to refer to figures and confirm what we think of the horse.

If these events are (sometimes) related, why is it that some horses that die of pulmonary haemorrhage with epistaxis do not show evidence of chronic EIPH? This is one of those $40,000 questions. It could be that young horses have had limited opportunity to develop chronic EIPH; it may be that we are wrong and the conditions are entirely unrelated. But it seems more likely that in these cases, the rhythm or conduction disturbance was sufficiently severe and/or rapid in onset to cause a precipitous fall in blood pressure with the animal passing out and dying rapidly.
In this interpretation of events, the missing link is the heart. There is no finite cutoff at which a case ceases to be EIPH and becomes pulmonary haemorrhage. Similarly, there is no distinct point at which any case ceases to be severe EIPH and becomes EAFPH (exercise-associated fatal pulmonary haemorrhage). In truth, there may simply be gradation obscured somewhat by variable definitions and examination protocols and interpretations.
It seems from the above that death should most likely take place during work, and it often does, but not always. It may occur at rest, after exercise. Death ought to occur more often in racing, but it doesn't.
The intensity of effort is only one factor in this hypothesis of acute cardiac or pump failure. We also have to consider factors such as when rhythm disturbances are most likely to occur (during recovery is a favourite time) and death during training is more often a problem than during a race.
A somewhat hidden ingredient in this equation is possibly the animal's level of emotional arousal, which is known to be a risk factor in humans for similar disturbances. There is evidence that emotions/psychological factors might be much more important in horses than previously considered. Going out for a workout might be more stimulating for a racehorse than a race because before a race, there is much more buildup and the horse has more time to adequately warm up psychologically. And then, of course, temperament also needs to be considered. These are yet further reasons that we have a great deal to learn.
These problems are something we cannot afford to tolerate, for numerous reasons—from perspectives of welfare and public perception to rider safety and economics. Our aim is to increase our understanding of cardiac contributions by identifying sensitive markers that will enable us to say with confidence whether cardiac dysfunction—basically transient or complete heart failure—has played a role in acute events.
We are also looking for evidence of compromised cardiac function in all horses, from those that appear normal and perform well, through those that experience haemorrhage, to those that die suddenly without apparent cause. Our hope is that we can not only identify horses at risk, but also focus further work on the role of the heart as well as the significance of specific mechanisms. And we hope to better understand possible cardiac contributions to EIPH in the process. This will involve digging deeply into some aspects of cellular function in the heart muscle, the myocardium of the horse, as well as studying ECG features that may provide insight and direction.

Fundraising is underway to generate seed money for matching fund proposals, and grant applications are in preparation for specific, targeted investigations.

Our studies complement those being carried out in numerous, different centres around the world and hopefully will fill in further pieces of the puzzle. This is, indeed, a huge jigsaw, but we are proceeding on the basis that you can eat an elephant if you're prepared to process one bite at a time.
How can you help? Funding is an eternal issue. For all the money that is invested in horses there is a surprisingly limited contribution made to research and development— something that is a mainstay of virtually every other industry; and this is an industry.
Look carefully at the opportunities for you to make a contribution to research in your area. Consider supporting studies by making your experience, expertise and horses available for data collection and minimally invasive procedures such as blood sampling.
Connect with the researchers in your area and find out how you can help. Watch your horses closely and contemplate what they might be telling you—it's easy to start believing in ourselves and to stop asking questions. Keep meticulous records of events involving horses in your care— you never know when you may come across something highly significant. And work with researchers (which often includes track practitioners) to make your data available for study.
Remember that veterinarians and university faculty are bound by rules of confidentiality, which means what you tell them should never be ascribed to you or your horses and will only be used without any attribution, anonymously. And when researchers reach out to you to tell you what they have found and to get your reactions, consider actually attending the sessions and participating in the discussion; we can all benefit—especially the ultimate beneficiary which should be the horse. We all have lots to learn from each other, and finding answers to our many challenges is going to have to be a joint venture.
Finally, this article has been written for anybody involved in racing to understand, but covering material such as this for a broad audience is challenging. So, if there are still pieces that you find obscure, reach out for help in interpretation. The answers may be closer than you think!
Consider supporting studies by making your experience and horses available for data collection and minimally invasive procedures.

Her career was short. Perhaps, had we known precisely what was going on, we might have been able to treat her, or at least withdraw her from racing and avoid a death during work with all the associated dangers— especially to the rider and the associated welfare concerns.
Had we had the tools, we might have been able to confirm that whatever the underlying cause, she had cardiac problems and was perhaps predisposed to an early death during work. With all the other studies going on, and knowing the issue was cardiac, we might have been able to target her assessment to identify specific issues known to predispose.
In the future, greater insight and understanding might allow us to breed away from these issues and to better understand how we might accommodate individual variation among horses in our approaches to selection, preparation and competition. There might be a lot of Oysters out there!
For further information about the work being undertaken by the University of Guelph
Contact: Peter W. Physick-Sheard, BVSc, FRCVS. Professor Emeritus, Ontario Veterinary College, University of Guelph. pphysick@uoguelph.ca
Research collaborators:
Dr Glen Pyle, Professor, Department of Biomedical Sciences, University of Guelph - gpyle@uoguelph.ca
Dr Amanda Avison, PhD Candidate, Department of Biomedical Sciences, University of Guelph. ajowett@uoguelph.ca
References
• Caswell, J.I. and Williams K.J. (2015), Respiratory System, In ed. Maxie, M. Grant, 3 vols., 6th edn., Jubb, Kennedy and Palmer’s Pathology of Domestic Animals, 2; London: Elsevier Health Sciences, 490-91.
• Hinchcliff, KW, et al. (2015), Exercise induced pulmonary hemorrhage in horses: American College of Veterinary Internal Medicine consensus statement, J Vet Intern Med, 29 (3), 743-58.
• Rocchigiani, G, et al. (2022), Pulmonary bleeding in racehorses: A gross, histologic, and ultrastructural comparison of exercise-induced pulmonary hemorrhage and exercise-associated fatal pulmonary hemorrhage, Vet Pathol, 16:3009858221117859. doi: 10.1177/03009858221117859. Online ahead of print.
• Manohar, M. and T. E. Goetz (1999), Pulmonary vascular resistance of horses decreases with moderate exercise and remains unchanged as workload is increased to maximal exercise, Equine Vet. J., (Suppl.30), 117-21.
• Vitalie, Faoro (2019), Pulmonary Vascular Reserve and Aerobic Exercise Capacity, in Interventional Pulmonology and Pulmonary Hypertension, Kevin, Forton (ed.), (Rijeka: IntechOpen), Ch. 5, 59-69.


The leading causes of horse mortality can be attributed to gastrointestinal diseases. Therefore, maintaining the balance of the gut microbiota and avoiding a shift in microbial populations can contribute to improved health status. The gut microbiota, however, can be influenced by countless dynamic events: diet, exercise, stress, illness, helminth infections, aging, environment and notably, antimicrobial therapy (antibiotics). These events can lead to gut dysbiosis—a fluctuation or disturbance in the population of microorganisms of the gut, which can contribute to a wide range of disease. The use of antibiotics in horses is thought to have one of the most notable effects on the gut microbiota (gut dysbiosis), which can lead to diseases such as colitis, colic and laminitis.
Antibiotics, which are antimicrobial agents active against bacteria, are important to equine medicine; and bacterial infections can be resolved quite successfully using antibiotics for antimicrobial therapy, but there are consequences to their use. An antimicrobial agent can be defined as a natural or synthetic substance that kills or inhibits the growth of microorganisms such as bacteria, fungi and algae. One of the consequences of antibiotic use is that of antibiotic-associated diarrhoea, which can contribute to poor performance in the horse and even mortality. In antimicrobial therapy, the target organism is not the only organism affected by the antimicrobial agent but also the commensal microbiota too (the normal flora of the equine gut). Antibiotics can promote fungal infections and resistant organisms and impede or even eliminate the more sensitive organisms; and they can have both short and long-term consequences on the gut microbiota composition and function.
Research has indicated that antibiotic treatment may adversely affect metabolic function in the gut by decreasing protein expression responsible for biochemical pathways such as glycolysis, iron uptake, glutamate hydrolysis and possibly even more metabolic functions. The use of antimicrobial drugs directly impacts and possibly contributes to the most notable effect on the gut microbiota of the host, leading to gut dysbiosis; and certain antibiotics can have further-reaching consequences on the microbiota than others. The type of antibiotic and mode of action (bacteriostatic versus bactericidal) will differ in their influences on the gut microbiota composition, e.g., clindamycin operates a bacteriostatic mode of action by inhibiting protein synthesis and exerts a larger impact on the gut microbiota compared to other antimicrobials.
These influential consequences that are imparted by the antimicrobial agent are relatively yet to be elucidated and may result in the manifestation of illness or conditions later in life. For example, the development of asthma in humans has been linked to antibiotic treatment in early childhood as a result of bacterial infections. It may yield interesting results if researchers were to examine the gut microbiome of horses suffering from chronic obstructive pulmonary disease (COPD) and other chronic respiratory illnesses and to establish if there is indeed a link with antibiotic therapy used in horses from an early age.
In comparison to the vast wealth of human studies conducted so far, the volume of equine studies falls disappointingly far behind, but that is changing as researchers focus their interest on developing and filling this gap of knowledge. One such study which examined the effect of antibiotic use on the equine gastrointestinal tract, demonstrated a significant reduction in culturable cellulolytic bacteria (>99%) from equine faeces during the administration period of trimethoprim sulfadiazine and ceftiofur in a study comparing responses to antibiotic challenge. That reduction was still evident at the end of the withdrawal period when compared to the control group. In other words, there was a significant reduction in the ‘normal’ bacteria of the gut. The ability of antibiotics to modulate the gut microbiota was evidenced by the proliferation of pathogenic Salmonella and Clostridia difficile (commonly associated with diarrhoea in horses) in the antibiotic challenged horses. This trend of reduction in cellulolytic bacteria associated with antibiotic use was also mirrored in a relatively recent study conducted in 2019, where a short-term reduction in culturable cellulolytic bacteria was combined with a progressive increase in amylolytic bacteria. The heavy reliance on cellulolytic bacteria in the role of equine digestion (without these types of bacteria the horse cannot break down their food) may, therefore, adversely affect the dietary energy available from forage during antimicrobial therapy and may therefore impact performance.
LEFT & ABOVE: It may yield interesting results if researchers were to examine the gut microbiome of horses suffering from chronic obstructive pulmonary disease (COPD) and other chronic respiratory illnesses and to establish if there is indeed a link with antibiotic therapy used in horses from an early age.


Another study that compared the effect of penicillin, ceftiofur and trimethoprim sulfadiazine (TMS) on the gut microbiota in horses using next-generation sequencing showed that TMS had the most profound impact on the microbiota, in particular the phylum Verrucomicrobia. This same study also reported a significant decrease in bacterial richness and diversity of the faecal microbiota. A reduction in bacterial diversity is certainly a trend that is commonly seen in gastrointestinal disease in horses. The restoration of the normal gut microbiota after completion of antibiotic treatment can take up to 40 days, but the organisational structure of the bacterial populations can take many years to reestablish the original structure map that was laid out in the gut pre-antibiotic treatment.
The equine studies certainly show similarities to the human studies, indicating the consequences of antibiotics that can be seen across more than one species. Human studies have reported long-term consequences of antibiotic treatment on the human microbiota. One such human study investigated a 7-day clindamycin treatment and monitored the patients for two years. The impact on the human microbiota remained evident two years post-treatment, where a reduction in bacterial diversity and detection of high-resistance to clindamycin were detected.
Interestingly, no resistant clones were detected in the control group over the two-year sampling period. Another study focusing on the effects of antibiotic treatment for Helicobacter pylori showed findings mirrored in similar studies of that field. The findings demonstrated the rapidly reducing bacterial diversity (one week) after antibiotic treatment and found that disturbances in the microbiota and high levels of macrolide resistance were evident four years post-treatment. Human studies may predict that equine studies will find similar trends with equine antimicrobial therapy. These studies highlight the impact of antibiotic use and the long-term persistence of antibiotic resistance remaining in the intestinal microbiome, which is a concern for both humans and animals.















Antibiotics can lead to the selectivity and proliferation of resistant bacteria, which is evidenced by the long-term effects observed on the gut microbiota harbouring drug-resistant encoded genes. Horizontal gene transfer (HGT) commonly occurs in the gut (can be up to 25 times more likely to occur in the gut than in other environments). HGT can be attributed to the close proximity of the microbiota in the gut, allowing the transfer of genetic material via routes such as plasmids and conjugation; in other words, the bacteria in the gut have developed a pathway to transfer antibiotic resistant genes from one generation to another. Resistance to antibiotics is now a global issue for the treatment of many diseases. With the unfavourable association tied to Clostridium difficile infections (CDI) and the onset of colitis particularly in mature horses treated with β-lactam antibiotics (commonly used for equine infections), the incidences in which antimicrobial therapy is considered should be minimised and only used if entirely necessary. The use of broad-spectrum antibiotics in recurrent presentations of symptoms of disease such as urinary tract infections in humans or diarrhoea as a result of CDI in both humans and horses is promoting drug resistance. The antibiotics, by disrupting the gut microbiota (which act as a defence against the establishment and proliferation of such pathogenic bacteria) are allowing the opportunity of growth for these multi-resistant microorganisms such as C. difficile, vancomycin-resistant enterococci (VRE), and multi-resistant Staphylococcus aureus
(MRSA). The organism C. difficile and its antibiotic resistance has been demonstrated in the treatment of CDI for both humans and animals. The introduction of vancomycin (a glycopeptide antibiotic) in 1959 for the control of CDI remained effective until the 1990s when a more virulent form of C. difficile emerged. This new form of C. difficile with reported broad-spectrum antibiotic resistance resulted in chronic conditions and increased human mortality. C. difficile is most noted with human hospital-acquired infections. C. difficile BI/NAP1/027 has been shown to have resistance to fluoroquinolone antibiotics, moxifloxacin and gatifloxacin, which was not seen in historical genotypes. As C. difficile infections are found to cause gastrointestinal disease in horses as well as humans, this is certainly of concern.

Alternative therapies to antibiotic therapy to restore or modulate the gut microbiome after a gut dysbiosis event could be considered in certain circumstances where antibiotics are no longer effective (e.g., CDI), nor may they not be the best course (presence of Extended-spectrum -β-lactamase producing (ESBL) organisms) nor essential for example, when the diagnosis of the bacterial cause is uncertain. The rationale to using probiotic treatment along with antimicrobial treatment is that the antibiotic will target the pathogenic bacteria (e.g., C. difficile) and also the commensal microbiota of the gut, but the probiotic bacteria will help to re-establish the intestinal microbiota and inturn prevent the re-growth of the pathogenic bacteria in the case or residual spores of C. difficile surviving the antibiotic treatment. Alternative therapies such as faecal microbiome transplant (FMT) or probiotic solutions can reduce the risk of proliferation of antibiotic-resistant bacteria and also have fewer implications on the gut microbiome as evidenced by antibiotic use.
Probiotics have been defined by the Food and Agricultural Organisation (FAO) and the World Health Organisation (WHO) as “live non-pathogenic microorganisms that, when administered in adequate amounts, confer a health benefit on the host”. The word ‘probiotic’ is Greek in origin, meaning, ‘for life’; and the term was coined by Ferdinand Vergin in 1954. While the mechanisms of action of probiotics are complex and require a deeper knowledge of the modulations of the gastrointestinal microbiota, and the health benefits due to their use are the subject of some debate, there is no doubt that probiotics are considered by many as a vital resource to human and animal health.




The use of probiotics in animal production, particularly in intensive swine and poultry production, has increased in recent years, primarily as an alternative to the use of antimicrobials in the prevention of disease. The problem of antibiotic-resistance and antimicrobial residues in food-producing animals (the horse is considered a food-producing animal), as a result of historical antibiotic use with the corresponding reduction in antibiotic efficacy in humans, leads to having to look at more sustainable options such as probiotic use to combat disease. Probiotics in horses are predominantly used as a treatment modality in the gastrointestinal microbial populations to combat illnesses such as diarrhoea—to prevent diarrhoea (particularly in foals) or help improve digestibility. Shifts or fluctuations in the microbial populations of the equine gastrointestinal tract have been associated with diseases such as laminitis and colic.
Gut dysbiosis, as mentioned previously is, a fluctuation or disturbance in the population of microorganisms of the gut is now being recognised as a cause of a wide range of gastrointestinal diseases; and in horses, it is one of the leading causes of mortality. The ability of probiotics in conferring health benefits to the host can occur via several different mechanisms: 1) inhibiting pathogen colonisation in the gut by producing antimicrobial metabolites or by competitive exclusion by adhering to the intestinal mucosa preventing pathogenic bacteria attachment by improving the function and structure; 2) protecting or restabilising the commensal gut microbiota; 3) protecting the intestinal epithelial barrier; 4) by inducing an immune response.
It is known that there is a wealth of factors that will adversely affect the gut microbiome, antibiotics, disease, diet, stress, age and environment are some of these compounding contributors. To mirror one researcher’s words echoing from an era where antibiotics were used as growth promoters in the animal industry, “The use of probiotic supplements seeks to repair these deficiencies. It is, therefore, not creating anything that would not be present under natural conditions, but it is merely restoring the flora to its full protective capacity”. In the case of using concurrent
antibiotic and probiotic treatment, this strategic tweaking of the microbiota could be used as a tool to prevent further disease consequence and perhaps help improve performance in the horse.

The benefits of probiotic use in horses have not been investigated extensively but as mentioned previously, they are now being focused upon by researchers in the equine field. The most common bacterial strains used in equine probiotic products are Lactobacillus, Bifidobacterium, Streptococcus, Enterococcus, Bacillus and yeast strains of Saccharomyces. Lactobacillus, Bifidobacterium and Enterococcus strains typically account for less than 1% of the microbiota large gastrointestinal populations. Regulation is lacking regarding labelling of probiotic products, often not displaying content with clarification and quality control (such as confirmed viability of strain[s]) not excised with overthe-counter probiotic products. There is evidence to suggest that host-adapted strains of bacteria and fungi enjoy a fitness advantage in the gut of humans and animals. Therefore, there may be an advantage in using the individual animal’s own bacteria as potential probiotics. Probiotics and antibiotics used concurrently could be the way to minimise the introduction of antibiotic-resistant bacterial strains in the gut, and in turn, protect future antibiotic efficacy.







“My philosophy is if you’re in something and you can get into a position where you can bring change about for the common good, that’s a thing to aim for. I’m not one for being a hurler on the ditch, give out and not try and do anything about it.”

Living true to his motto, Dermot Cantillon ran for election to Seanad Éireann— the upper house of the Irish Legislature (the Oireachtas)—two years ago. He was prompted to do so, even though he had no political background or experience, by a firm belief that horse racing and the bloodstock industry lacked representation despite their significance to national and local economies.
As an independent candidate, the Co Waterford native was up against the powerful party machines with their established lobbies and financial clout, so it did not come as a big surprise he did not make the cut. But he would not have been true to himself and his ideals had he not had a go.
Proactivity is a default setting for Cantillon, who along with his equally industry-immersed wife Meta Osborne, owns and runs Tinnakill House stud farm in the Laois village of Coolrain. As a man who has walked the walk and continues to do so, he is always worth listening to on matters pertaining to the sport and business of thoroughbred racing.
Apart from being a breeder of multiple Gp. 1 winners and overseeing a flourishing enterprise for two decades, Cantillon has also helped steward the massive strides made by Naas Racecourse in 13 years as chairman.
In addition, the 62-year-old is chairman of Irish Thoroughbred Marketing, a director of Goffs and board member of the Irish Equine Centre. Previously, he has served as chairman and president of the Irish Thoroughbred Breeders’ Association, chairman of Tote Ireland and director of Horse Racing Ireland.
He also served as manager of the Smurfit family’s Forenaghts Stud outside Naas for 32 years until standing down two years ago. This is a polymath on breeding, selling and running racehorses.

Osborne is the daughter of Michael, the late Irish Turf Club (IHRB) senior steward and Irish National Stud managing director. He was also the creator of Dubai as an international racing venue and of Sheikh Mohammed’s stud operations in Ireland. Meta would follow in her father’s footsteps by becoming the first woman—and still the only one—to be Turf Club/IHRB senior steward and is a current HRI director.
She is Kildangan Stud’s chief vet, having worked there for 34 years, while her family has been inextricably linked with Naas Racecourse since its foundation.
She and Cantillon make a good couple and that they don’t agree on everything is a positive. Among the many things they shared a page on was the desire to own their own stud. They bought Tinnakill in 2002 when it was a sheep farm, and the fecundity of the land and broodmares that have inhabited it since has propagated substantial success. Among the stellar cast of those bred there are Alexander Goldrun, Red Evie (dam of Arc-winning Breeders’ Cup heroine Found) and Casamento.
As a four-time Gp. 1 winner in four countries and three continents before injury brought his career to a premature conclusion last month, State Of Rest is the best though.
Due to the colt’s astounding feats in adding the Prix Ganay and Prince of Wales’ Stakes this year to last season’s Saratoga Derby and Cox Plate triumphs, Juddmonte made a bid for the son of Starspangledbanner’s 10-year-old Quiet American homebred dam Repose, who is in foal to Frankel.
“To be perfectly honest, like most Irish people in the industry, I’m a trader at heart,” Cantillon relates. “By definition then, if a big enough offer comes along, you’re gonna sell. Legacy is important but at the same time being able to meet your commitments for a long period of time and the security of that is also very important; and that won it over for me. She became too valuable a mare nearly to hold on to in proportion to the other mares I had. She was worth nearly more than everything else put together. That’s a total imbalance.
“We have a philosophy to buy taproot-type females in outstanding American and European families, and she was the embodiment of that in that her dam Monaassabaat, who we bought initially, was out of It’s In The Air, who was one of the best mares in America ever (five of her 16 triumphs were Gr. 1’s) and also a fabulous producer. So it was an overnight success that took 15 years.”
Despite the windfall, Cantillon will not be splurging unnecessarily, though he will look to improve the lowest bar. With around 40 mares, Tinnakill focuses on quantity; and thanks to their canny approach and eye for a bargain, that tends to produce some quality along the way.

“We don’t spend a lot at the sales. We buy mares from one grand to maybe seventy five. That’s the comfort zone for us, and that’s where we intend to stay. To be successful at that level, you need a lot of mares; and you hope some will make it big for you. The philosophy is probably to throw enough at the wall and some of it will stick.”
They are willing to sell their homebreds at any stage up to and including as a racehorse but will not be forced into accepting a price that doesn’t match their value.

“I see five different opportunities to sell along the way. The first one is in utero, the second one is the foal, the third is yearlings, the fourth is breeze-ups and the fifth one—the ultimate one—is in training. So within the philosophy of business, all five operate—and I’d say more so now, the fifth one. To show confidence in our own yearlings especially, we’ll keep 25 percent in them in partnership if whoever buys them asks us to do so. We’ll go to the next level on the understanding that if they prove themselves on the racetrack, they will get sold in a commercial way.
“We’d predominantly be known as foal sellers, and we sell a lot of foals in England and Ireland. People want foals that they can bring to the Orby and so on, and we sell those sort of foals. If they make money, so be it.
“We tend to keep any foal after the 15th of April. People have an idea of what a foal should look like—it’s a good, strong foal. As they head towards a May foal, the discount that you’re expected to take can be fairly big, so we don’t tend to bring the later foals to the foal sales; they tend to go on to the yearling sales. At the yearling sales, we bring mostly foals we failed to sell because we didn’t get what we thought the foal should’ve made, and also later foals.”
The demand for precocity and immediate results has inflated that specific market, but that means there is value for discerning buyers.
“What happens at yearling and foal sales is that people have a certain view of what a good foal or a good yearling should look like, and most people have exactly the same view. So if you have that particular product, you get a big premium. But for people buying horses, I think the value is slightly to either side and for a deviation of 10 percent, you might get a discount of 50.
“So if you can forgive some slight physical flaws, these are going to be discounted significantly; and I think there’s great value if people can get away from perfection to look upon the foal and yearling more as an athlete with slight imperfections but at the same time, an athlete.
“I think for that reason trainers probably make the best buyers because they’ve seen it all, whereas often, agents are under pressure to buy the horse that ticks all the boxes.”
Fashion also applies to stallions and again, Cantillon is imaginative when it comes to where he sends his mares. He has said previously that he likes to go against the tide when selecting stallions.


“I like to breed to middle-distance horses. Last year, I bred five mares to Australia. I think he’s a very good stallion. He can get you a two-yearold, he can get you a good three-year-old, he can get you a horse you can sell to Australia for a lot of money if it shows some form. The demand for middle-distance horses is enormous and very lucrative.
“The only time I would be breeding to ‘expensive stallions’ would be a foal share. I wouldn’t be putting more than 30 or 40 grand into any mare, barring we owned a nomination. I do invest in a lot of stallion shares, and to a large extent, that dictates what my mare is going to.
“I think it’s a great business move. It’s not without risk, but you can buy a stallion share; and in most cases, you’ll get most of your money back within three or four years. And if it hits, you’ll get many multiples of it. So, I think, if you’re in the industry, you have a nucleus of mares that you can use these nominations on, it makes huge sense economically to invest in stallion shares.”
He sees the economics of horse breeding as being cyclical and thus predicts a significant downturn in two or three years, with the thoroughbred industry tending to “have a significant correction” within a couple of years of a societal recession.


There is no hint of doom in these utterances, given that he has always cut his cloth to measure, and he expects any shrewd operator to insulate themselves in preparation for what’s down the tracks. Indeed while he has expressed concern for the smaller breeders in the past, he believes the environment is more conducive to them getting a positive return for their investment now.
“I think it’s a bit healthier than it was. The top end was very lucrative and is still very lucrative, but maybe there aren’t as many players at the very top end where there’s a lot of players in the middle tier now.
“I think that ITM and the sales companies in Ireland have done a great job in attracting American buyers. There was a significant increase in yearlings going to America from the Orby Sale last year. That’s a tremendous result. To some extent, the American market is replacing the Maktoum market in Ireland. And when you look at history, you always see that major players come and go; but the industry always survives, and I think now the American market is going to get better and better.

“There’s a couple of factors there. The injuries in turf racing are less, the number of participants in turf races are more, and that’s good from a gambling point of view. And the fact we’ve sent a lot


of horses over to America now, they’re acting as advertisements for the next bunch, and they’re doing exceptionally well. So as night follows day, I think that at the upcoming yearling sales, the American influence will be huge.
“I think Charles O’Neill (ITM CEO) has done an outstanding job. To see him in action internationally is a joy to behold. That’s a role that takes a long time to get people’s trust. Our industry is based on trust, but he has it now; and a lot of markets have been opened up year-in, year-out by him visiting these places with his team. Over time there’ve been very lucrative transactions, especially for horses in training, as a result of that.”
Back at home the evolution continues, and Cantillon’s entrepreneurial son, Jack, has become a key part of a team in which manager Ian Thompson is also a vital cog.
“I think Jack is a good catalyst because he pushes you. A lot of the accolades have to go to him because I’d be at the sales sometimes and he’d be after buying a mare without me knowing. He’d never buy a mare I wouldn’t have bought myself, but he pushes the boat out more than I would and that keeps me on my toes.”
I THINK THAT ITM AND THE SALES COMPANIES IN IRELAND HAVE DONE A GREAT JOB IN ATTRACTING AMERICAN BUYERS. THERE WAS A SIGNIFICANT INCREASE IN YEARLINGS GOING TO AMERICA FROM THE ORBY SALE LAST YEAR. THAT’S A TREMENDOUS RESULT. TO SOME EXTENT, THE AMERICAN MARKET IS REPLACING THE MAKTOUM MARKET IN IRELAND.”
Among Cantillon Jnr’s interests is Syndicates.Racing, which focuses on the fractional ownership model and has been a resounding success on both codes in a very short span of time. The founder’s proud parents have shared the journey, and Dermot emphasises the importance placed on having a positive race-day experience. This is a central tenet of all the improvements that have taken place at Naas during his tenure.
“In terms of building the new stand, the whole concept of it was to bring the horse into the main focus. You look to your right, and you have the horses in the parade ring along with the actors—the jockeys, the trainers—you have that whole environment there. Then you look to the left, and you see where the horses will be participating. So the whole philosophy of that stand was to bring the horse more into focus.”
Osborne calls Naas her husband’s “fifth child,” and it has certainly flourished in an atmosphere that promotes and encourages imaginative thinking. Former manager Tom Ryan oversaw much of the improvement, and Eamonn McEvoy continues in a similar vein.
“The philosophy is ‘never stop.’ What’s next? Eamonn has done a super job. He’s a very progressive, inclusive person. He tries to bring everybody with him.”
Rewards have come in the form of the upgrading of the Lawlor’s of Naas Novice Hurdle to Gr. 1 status and being asked to take up the slack during The Curragh’s redevelopment. But there is clear impatience about the difficulty in climbing further up the ladder. Not yet having a Gp. 1 race on the flat is especially annoying.
“My big frustration is that within the whole structure of Irish racing there’s no pathway in how you can get better. How do you go from being classed as a second-grade track to being one of the elite tracks? I’ve asked this question five years, six years now, and nobody has been able to tell me. How do we change it so that the 13 Gp. 1 races in
Ireland are not divvied out every year to two tracks? Why can’t other tracks that have a good proposition get one of those races? Why don’t we challenge the status quo for the benefit of Irish racing? Nobody’s been able to tell me why not except that they won’t rock the boat.

“Convention is an easy way of management, but it’s not the progressive way.”
In any high performance network, the existence of a clear pathway provides an incentive for improvement and as a consequence, raises standards. Why do more than trouser the media money if it doesn’t matter what you do?
“That’s exactly it. That’s what we’ve been told for generations, more or less. There are little tweaks where they give progressive tracks like Naas additional fixtures; and also, we’ve been able to increase our black-type races. But at the same time, there’s a glass ceiling there, and we need to break that for the good of Irish racing. We need to be progressive. We’re not progressive. We just maintain the status quo.
“There’s two ways we can get a Gp. 1. The first is to have an existing Gp. 1 transferred from another racecourse. The other way would be one of our races, over time because of the ratings, would qualify as a Gp. 1. At this point in time, there are one or two races that we would think could be due to be upgraded, but it hasn’t happened yet and that’s frustrating.”
There are some “outside the box” plans that are being considered at the moment that include some potential ground-breaking global partnerships. Further enhancements for the course are also in the pipeline.
As for the racing product itself, he believes maintaining quality is critical.


“My view of Ireland: we’re like what the All Blacks tend to be in rugby. If a horse wins a good two-year-old race in Naas, then he’s marketable to the whole world as that’s as good as you can get in terms of a young horse and where he’s performing. I have a lot of sympathy that everybody gets a run because I have some bad horses myself that can’t get into races, but I think it’s very important that we maintain the brand.”
He believes that the betting tax should be limited to winnings for off-course bookies but be increased to three percent. This would lead to a likely increase in funding for racing, he argues. It would also go some way to arresting the decline of the on-course betting ring that used to be central to the race-day experience.

“We need to give an advantage to bookies on track. There needs to be something which makes you go racing if you want to bet and a differentiation between off-track and on-track in terms of the three per cent could be a big help.
“When I was on the board at Naas first around 25 years ago, a very good race meeting could turn over a million pounds on-track. Now we’re looking at 150 (thousand). There’s a crisis. We need to do something radical about the crisis. My solution would be to have no tax on-course and increase the tax off-course on winnings.”
This might also help increase attendances, which despite what some industry leaders suggest, has to be a cause for concern with racing’s supporters getting older by the year.
“We’re nearly totally dependent on media rights money to operate the racecourse. You could do a strength-and-weakness analysis, and a massive weakness is its dependence on the media rights. Because of the media rights, we’ve maybe neglected the attendance.
“We now have a new audience, which is the digital audience and… people don’t travel to race meetings like they used to, so the emphasis has to be on the local audience, and we have identified that at Naas. We have taken a number of steps, and we’re going to take more to be more and more part of the Naas community. If we’re going to get people back racing, we see our growth within Naas and its environs.”
It is a recipe that has worked for a number of regional venues but has not yet been utilised, successfully at least, by too many. And as Cantillon has already suggested, media rights income has removed much of the incentive to bother doing so.
That said, he understands the disappointment of some of the smaller racecourses that feel the distribution of the media rights income has been inequitable.
“Something like an extra seven-to-nine percent went back to central funds when the last agreement was made. I was in the room when the thing was voted on, and people were looking at how much extra they were getting; and they were so happy about how much extra they were getting, they didn’t really think of the implications of giving an extra seven or eight per cent to Horse Racing Ireland. Horse Racing Ireland said, ‘Oh that’ll all come back in grants.’ And as a totality, it came back in grants. But for certain racecourses, it didn’t come back proportionally because if a track couldn’t come up with 60 percent of the cost, they wouldn’t get the 40 percent grant; and I understand their frustration.”
The current deal concludes next year, and he yearns for a “unified approach” towards negotiating the next one. But whatever unfolds, positive or negative, Dermot Cantillon will be putting his best foot forward. He knows no other way.

WE’RE LIKE WHAT THE ALL BLACKS TEND TO BE IN RUGBY. IF A HORSE WINS A GOOD TWO-YEAR-OLD RACE IN NAAS, THEN HE’S MARKETABLE TO THE WHOLE WORLD AS THAT’S AS GOOD AS YOU CAN GET IN TERMS OF A YOUNG HORSE AND WHERE HE’S PERFORMING.”

The new rules and regulations became United States federal law in December 2020. The Horseracing Integrity and Safety Authority (HISA) is responsible for drafting and enforcing safety and integrity rules in thoroughbred racing across the U.S. Overseen by the government’s Federal Trade Commission (FTC), HISA is implementing a national, uniform set of rules applicable to all thoroughbred racing participants and racetrack facilities.
HISA comprises the Racetrack Safety Program, which went into effect 1 July 2022, as well as the Anti-Doping and Medication Control (ADMC) programme, which will be implemented in January 2023. The ADMC will impact next year’s Breeders’ Cup.


According to Lisa Lazarus, chief executive officer of HISA, the Racetrack Safety Program includes operational safety rules and national racetrack accreditation standards, seeking to enhance equine welfare and minimise horse and jockey injuries. This programme expands veterinary oversight and imposes track surface maintenance and testing requirements. It also enhances jockey (and exercise rider) safety, regulates riding crop use and implements voided claim rules, in addition to other measures.
The ADMC programme will create a centralised testing and results management process while applying uniform penalties for integrity violations across the country. The rules and enforcement protocols will be administered by a new independent agency, the Horseracing Integrity and Welfare Unit (HIWU), which was established by Drug Free Sport International (DFS).
HIWU will oversee testing, educate stakeholders on the new system, accredit laboratories, investigate potential integrity violations and prosecute those breaking rules and protocols.
HISA completed and pending rules and regulations can be found at https://www.hisaus.org.
Not everyone required to opt into the Horseracing Integrity & Safety Act is pleased to oblige. The confusing regulations have left many with less than a clear understanding of what the new rules actually mean. Those details have constantly been modified and most likely will continue to fluctuate as flaws in the statute are arbitrated.
The legislation timeline—a very rapid implementation— did not leave an abundance of time for the busy and independent members of the racing community to thoroughly digest the new rules and oversights: In a hurry, they are being asked/required to become obligated by registering themselves and their horses. Horsemen felt left in the dust.
Breeders’ Cup contestants travelling to Kentucky this fall will have more to worry about than flight delays and shipping reservations. Owners, trainers and jockeys will need to bone up on new racing regulations now enforced across America. It appears they are well into that task.
HISA is now, however, in the process of adding a means for horsemen to have a bigger voice in forming regulations and protocols—a complaint horsemen have had since the onset is being excluded from the process. Lazarus announced her executive team would be selecting 10–12 horsemen to participate on the Horsemen’s Advisory Group.

Barry Irwin, founder and chief executive officer of Team Valor International, has been promoting additional integrity in the racing industry for two decades or longer. As a turf writer, breeder, owner and bloodstock agent for over 50 years, Irwin looks forward to implementation of the ADMC. He might have hoped for a smoother execution of HISA, but he is glad things are progressing.

“The safety element is so big and all encompassing, some people may think overreaching, that it stalled the implementation of the integrity piece,” Irwin opined. “There is a lot of good in it; there is a lot of confusion in it. Part of the confusion stems from the perceived lack of input and influence of the people to whom these rules apply.
“A lot of trainers are [unhappy] because there are a bunch of [changed] procedures that they have been using for years, such as blistering horses, pin-firing horses—things like that. There are growing pains, so they have invited horsemen to join an advisory committee for input now and in the future, which I found to be a good thing. It’s just a little late.”
People responsible for registering horses, usually the trainer, are required to keep precise records for each animal. Most horsemen have a vivid aversion to bookkeeping; they’d much rather concentrate on training horses and keeping owners happy and informed.
Most countries require medical and procedural records be kept on their equine competitors. HISA also requires trainers and veterinarians to maintain detailed, daily health and treatment records for equines in their care. This also applies to international trainers temporarily in town for major races. Those records must be made available to regulatory veterinarians, stewards and HISA upon request. Imagine the daily hours to keep up with a barn full of trainees. There is a solution—a software programme—to ease the struggle.
Equine MediRecord became operational in 2018. It was the brainstorm of Pierce Dargan in County Kildare, Ireland. Dargan, a fifth generation horseman, is the company’s CEO. Dargan’s system was created for his family’s training operation in Ireland, to help keep current with racing regulations they faced at the time.
Trainers can sign up for Dargan’s company platform, which allows them to keep the tedious records required by HISA. Those with multiple stables and facilities can add assistant trainers and veterinarians to assist with inputting information.
“What our system then does is notify the trainer when a record has been put in by someone else for them to sign off, ensuring they know at all times what is being given to their horses,” Dargan explained. “Any horse with an open treatment on our system will [be marked] to remind the trainer to check this horse before entering into any races, as there is still a treatment in the horse’s profile; this ensures the withdrawal period is completed before they race.”
Presently, the cost is $1.50 per horse, per month for the initial year, increasing to $3.00 per horse/month the second year. “We wanted to make sure this was a tool that all trainers, big and small, could afford,” Dargan said. “One of the benefits of having clients globally is we can spread the costs, making it cheaper for all.” “We have done the Breeders’ Cup World Championships for the last two years, as well as the Pegasus World Cup, Saudi Cup and Preakness in 2022,” Dargan pointed out.
International Breeders’ Cup entries and connections appear prepared to take on HISA, although there could be a few speed bumps on the road to America.


Not registering for HISA—no matter what continent you hail from—means a person or horse may not participate in U.S. racing. Once signed up, however, being misinformed or not following the rules can land people and equines severe punishments, large monetary fines and/or disqualification from industry participation.
Early in the process, HISA’s website was not particularly user friendly, but those issues have been worked out for the most part. International connections preparing to run in major U.S. races initially registered with HISA prior to entering or declaring to run. However, to register for HISA, one needs to be licenced in the state where they will be running. Some states, like New York, require digital fingerprinting of the licensee by track personnel, causing problems for horsemen in far away corners of the world.
“HISA has made it impossible to do things on race day,” explained Adrian Beaumont, director of Racecourse Services for the International Racing Bureau in Newmarket, England. “Therefore, we had to be proactive and get connections licenced beforehand. This often means having to get connections fingerprinted in advance of the meeting. This was especially true of connections, like owners, who would not be going to the races but still needed a HISA registration. New York Racing Association made their cut-off time for HISA as 10 a.m., scratch time, on the day of the race.”
According to Beaumont, HISA’s Lisa Lazarus organised a Zoom call, for Breeders’ Cup principles, including Japan, on 16 September. “I will be interested to know the timeframe they will require all HISA registrations to be completed by, especially as declarations to run are due on Monday, October 31,” added Beaumont.

While the Lazarus Zoom call may flatten some organisational speed bumps, the initial dismay for HISA created a flurry of ongoing legal actions by several state racing commissions, jockey organisations, different Horsemen’s Benevolent and Protective associations and other groups. North American Trainer magazine
contributor and equine attorney Peter J. Sacopulos expressed the issue in the magazine’s Issue #65 - Summer 2022, on page 48. In the article, Sacopulos questions how HISA affects international trainers and owners.
“In registering, the foreign national trainer is responsible for and obligated to fully and completely understand and comply with all HISA requirements. Once properly registered and deemed a ‘covered person,’ the foreign national trainer has certain ongoing obligations. For example, Thoroughbred trainers are required to complete four (4) hours of training annually pursuant to Section 2182(b)(5) of the rules governing the Racetrack Safety Program. Additionally, there are requirements for filing records relative to the medical care and treatment of horses. Also, the licensing and ongoing requirements for covered persons apply to owners of Thoroughbred horses. Therefore, it is recommended that the Thoroughbred trainer who is going through the registration process informs his or her owner of those requirements and sees that the owner(s) are properly registered as covered persons.”
It gets complicated.
Beaumont was somewhat surprised by the requirement for jockeys to have an annual baseline concussion test as part of the HISA registration. Riders in England and Ireland have concussion baselines done every two years. French jockeys are not required to have annual baseline concussion tests.


The chief medical officers at the main European Jockey Clubs and the Jockeys’ Associations are now aware of this test requirement. Beaumont recommended their website as informative and helpful.
https://jockeyclub.com/pdfs/HISA/HISA_Jockey.pdf
“It is the jockeys [who] require the extra briefing about all the rules,” Beaumont said, “but we will do that with them all before race day. “At the last two Breeders’ Cups, the stewards have also briefed all the jockeys about their rules on the mornings of the races. This will obviously now include any extra regulations brought in by HISA.”
Jockeys with Breeders’ Cup mounts will need to study HISA restrictions for use of the whip, which in some cases are similar to, yet vary from, European rules.
Until the limitations on use of the whip become muscle memory, riders are finding themselves punished for extra strikes or improper handling of the whip. Numerous penalties have been dished out to even the best of the American riding colony thus far. One costly example occurred last month.
Jockey Luis Rodriguez-Castro was fined $500 and suspended three days for his ride on Drafted (Field Commission) while finishing fifth in the Forego (Gr. 1) at Saratoga in New York. The rider’s violation was striking Drafted with the whip ten times during the race. HISA rules allow only six strikes during a race; Rodriguez-Castro’s four strike overage cost the horse’s connections $26,000 in purse money.
But Germany and other European nations are also inflicting stringent rules on riders who are overly aggressive with crop use.
German-bred Torquator Tasso, winner of last year’s Qatar Prix de l'Arc de Triomphe (Gp. 1), finished a near second to Mendocino in Baden-Baden, Germany. Jockey Frankie Dettori felt the sting of striking his mount one time too many with a 14-day suspension.
Strict German whip rules permit for the crop to be used only five times during a race, with the use of it down the shoulder with hands on the reins still considered as one strike.
3 1-3 strikes over 6-strike limit
A jockey or exercise rider can only use a riding crop in a race or workout:
• To maintain the horse’s focus & concentration for the safety of both horse & rider
• For encouragement to achieve optimal performance
The crop CAN be used during a race or workout:
• On the horse’s hindquarters no more than 6 times & in increments of no more than 2 strikes before allowing horse to respond for at least 2 strides
• To tap the horse’s shoulder while both hands are holding the reins & touching neck
• To show or wave to the horse without making contact
• To preserve your & your horse’s safety
The crop CANNOT be used:
• If your wrist is raised above your helmet
• Anywhere except the horse’s shoulders or hindquarters
• In a manner that injures the horse or leaves physical marks
• Persistently without response from the horse
• After the horse has attained its maximum placing in the race
• During the post parade or after the finish of the race unless you are avoiding a dangerous situation
• On two-year-old horses in races before April 1 each year unless you are avoiding a dangerous situation
• To strike another person or horse
When a jockey rides without a crop, that fact shall be declared at entry, included in the official racing programme and announced via the racetrack’s public address system.
2 4-9 strikes over 6-strike limit
Fine: $250 or 10% of jockey’s portion of purse, whichever is greater Jockey suspension: 1+ day 3 Points (expire after 6 mos)
Fine: $500 or 20% of jockey’s portion of purse, whichever is greater Horse disqualified from purse earnings Jockey suspension: 3+ day 5 Points (expire after 9 mos)
1 10 or more strikes over 6-strike limit
MULTIPLE
MULTIPLE
points
Fine: $750 or 30% of jockey’s portion of purse, whichever is greater Horse disqualified from purse earnings Jockey suspension: 5+ day 10 Points (expire after 1 yr)
jockey suspension
points 15-day jockey suspension
MULTIPLE 20+ points 30-day jockey suspension
HISA: Horseracing Integrity and Safety Authority
ADMC: Anti-Doping and Medication Control
FTC: Federal Trade Commission
HIWU: Horseracing Integrity & Welfare Unit
DFSI: Drug Free Sport International
THA: Horsemen’s Advisory group
BHA: British Horseracing Authority

IRB: International Racing Bureau
Team Valor International races horses in Germany, and Barry Irwin voiced respect for their programmes in general and regard for their accomplishments with smaller thoroughbred crops of 750 to 800 foals; Torquator Tasso is an example.
“[Germany] has a lot of rules, and they are different from England, Ireland and France,” Irwin said. “You can’t use a tongue tie, for example. I don’t know any other jurisdiction that does that. They are very good at testing, and they have a lot of rules about bleeders.”
Handling and properly holding the whip have become strict and exacting in many racing nations. A BHA steering group has proposed 20 changes to their current whip rules in four areas—how the whip is used, changes to regulation, changes to enforcement, plus other recommendations. (See page 48)
“Most of our jurisdictions are run as tightly, if not more tightly, than your new HISA rules over in the states,” Beaumont pointed out. In some countries, such as Denmark, Norway and Sweden, whips are banned. Most other countries have strict rules on the
use of the whip in terms of how many times a horse can be hit and where they can be hit.”
“The new rules, which are likely to come into force with BHA, include using [the whip] in the backhand position only,” he added. “There are examples every week of jockeys getting fined and banned for use of the whip, and generally longer suspensions than in the states.”
HISA regulations overall are not so dissimilar from other international edicts. There are so many variables, geographically for one, that synchronising worldwide regulations may never come to fruition. But, it’s a thought for the future.
When the ADMC portion of HISA kicks into gear the first of next year, there will likely be even more details to be digested by horsemen and other stakeholders. After all, that was the initial consideration when seeking reforms.
Irwin has “great hope” that those marring the integrity of thoroughbred racing will be prosecuted and severely penalised, and that the punishments will be severe enough to stop the cheating.
“As for the Anti-Doping and Medication Control regulations for 2023, I await their details,” said Beaumont. “Of course, we are already subject to strict restrictions over here, so this should not be an issue. Every horse shipping to run at Breeders’ Cup, for example, will already have done an out-of-competition test sanctioned by the state governing body and carried out by the likes of BHA on their behalf.
“They have a tough task,” Irwin said of HISA. “There are so many elements, groups to try to appeal to—it is a tough job.”
1. Use of the whip for safety purposes should continue to be a fundamental principle of regulation.
2. The Rule requiring the whip to be carried (though not necessarily used) should be retained.
3. Use of the ProCush whip should continue to be permitted for encouragement, with strong and appropriate regulation for its use.
4. The whip rules will be amended to restrict use for encouragement to the backhand position only.
5. Harmonisation of whip rules and penalties is a positive aspiration. The BHA should continue to play a leading role in discussions about harmonisation with its international counterparts, particularly Ireland and France.
6. The regulatory approach to the whip should be reframed to drive continuous improvement, both in standards of whip use and in the consistency of stewarding.
7. Official guidance notes relating to some aspects of the whip rules should be refined and improved, so they are less ambiguous and open to interpretation, and to ensure greater consistency in the enforcement of the rules.
8. A review panel will be established, which will assess all potential whip offences and apply sanctions or remedial actions where appropriate. The panel will deal with referrals from the Stewards, as well as having the power to initiate its own review.
9. The threshold for the application of some whip penalties will be lowered, to increase the deterrent effect and ensure earlier intervention.
10. Penalties will be increased for some specific offences where the current penalty is considered inadequate.
11. Financial penalties applied to amateur riders for whip offences will be increased.

12. The penalty structure for use of the whip above the permitted level, which are the most frequently committed offences, will be revised to increase the deterrent effect.
13. Penalty structure for use of the whip above the permitted level in major races to be revised as a doubling of the suspensions for the same offence in standard races.
14. Repeat whip offences should be addressed at an earlier stage, and the penalties for repeat offences increased to deter further repetition.
15. Disqualification of the horse will be introduced into the penalty framework for particularly serious use of the whip above the permitted level, where there has been a clear and flagrant disregard for the rules.
16. The BHA, on behalf of the racing industry, should commission and support further objective research into the effects of the whip, using any relevant scientific advances to inform policy.
17. The BHA should regularly consider the design and specifications of the approved whip, with a view to incorporating any technological innovations or advances that could further improve equine welfare and safety.
18. Reasonable efforts should be made by British racing to explain the design, use and regulation of the whip to key audiences.
19. While changing the name of the whip is not a direct, formal proposal, racing participants and media should be encouraged and supported to speak about the whip using appropriate and responsible language.
20. The BHA and racecourses should agree a standard rider contract for charity and legends races, to ensure riders in such races are clear on their obligations in relation to use of the whip.

































































The Racing Foundation was delighted to welcome more than 200 delegates to the fifth annual Horseracing Industry Conference at Newbury Racecourse. Held on June 30 in partnership with the University of Liverpool Management School, the event was attended by leading figures from across the horse racing industry.
The conference’s headline topic was titled: “A healthy balance: balancing economic, environmental and social health to ensure a sustainable racing industry.”
The conference gave keynote speakers the opportunity to address the challenges affecting the horseracing industry in Britain.
Rob Hezel, chief executive at the Racing Foundation, said: “When developing the agenda for this year’s Horseracing Industry Conference, we did so with the belief that the long-term sustainability of the sport depends on three things: economic, social and environmental health.
“The growth in the event and its popularity demonstrates to me the real need for a forum for the multitude of organisations and businesses that make up British horseracing to meet regularly and to challenge and support each other.
“We had a vast range of talent in the room from a great variety of organisations. If the Racing Foundation can assist in aligning and coordinating them, then we are adding real value to the industry.”
Joe Saumarez-Smith, chair of the British Horseracing Authority, kicked off the conference with his first keynote address since taking on the position earlier in the year.
The importance of data collection and how the British racing industry understands and uses that data was cited by Saumarez-Smith as crucial to the sport’s future.
The economic section of this year's conference commenced with Peter Hawkings, strategy consultant at Portas Consulting, analysing the funding structure of British racing.
Hawkings warned that the British racing industry would have a low growth rate over the next five years should intervention not take place. Seven potential levers to improve British racing’s financial position were subsequently offered:
· Build relationships with fans and make the sport more relevant
· Create new, exciting racing formats and greater narratives across the year
· Convert more fans to becoming fractional owners (syndicates)
· Secure owners in new geographies
· Optimise racing as a betting product

· Achieve meaningful levy reform
· Diversify racecourse revenue streams (e.g., becoming more of a 365-day event destination)
Continuing on the theme of the economic challenges of racing, “How People Bet on Horseracing and the Implications for the Sport’’ was the title of University of Liverpool’s Professor of Economics David Forrest’s keynote talk. He took delegates through the findings of the Patterns of Play project, initiated by the Gambling Commission and GambleAware.
The project was intended to yield a description of how people gamble online, primarily with the intention of informing policy for harm reduction and analysed data from 14,000 online betting accounts.
The University of Liverpool professor explained that the Patterns of Play data revealed risks to racing’s implicit business model.
Even relative to the other gambling activities that were studied as part of the project, spending on race betting was found to be very concentrated indeed with its revenue stream very dependent on a small number of the population.
Indeed, the study found that the top one percent of gamblers on horse racing provided 59 percent of total stakes. One risk highlighted by Forrest was the possibility that the activities of these high-spending gamblers may generate regulatory interventions which could curtail their levels of activity.
More than 200 delegates to the fifth annual Horseracing Industry Conference at Newbury.

Forrest then explored the age range of participants in online horse race betting, finding it relatively high in all age groups. Horse race betting was found to attract only a relatively small share of betting spend in younger age groups, with more than 55 percent of horseracing gross gambling yield generated by those aged 45 or above.
If the younger half of the population maintains these preferences as they age, Forrest warned, there is likely to be a secular decline in racing’s revenue stream. This data illustrates a medium and long-term threat to the sustainability of British racing at its current scale of activity because those who are currently in younger cohorts clearly have a stronger preference for sports betting (predominantly football) than for horse betting.
A fundamental issue for British racing, Forrest warned, is that the senior age range for all British racing’s customer groups, including racegoers, television viewers, gamblers and owners, poses a threat to the future prospects for the sport.
Crucial to the health of British racing is the sport’s social licence. Next on the agenda, conference delegates heard an analysis on the impact of equality, diversity and inclusion (ED&I) in British racing in a talk that explored whether it was making progress in British racing or was merely ticking boxes.

The talk was hosted by Lee Mottershead, Racing Post senior writer and member of the sport’s Diversity in Racing Steering Group. Mottershead quizzed industry leaders including Chief Executive of the British Horseracing Authority Julie Harrington on the sport’s responsibility towards ED&I. Mottershead was also joined onstage by Urban Equestrian Academy founder Freedom (a.k.a. “FR33DOM”) Zampaladus, who offered honest insight into his experiences in horse racing as an individual from a historically underrepresented background.
Two members of the recently appointed project team at the Horse Welfare Board were next to present and sparked heated debate amongst the delegates present.
AT THE RACING FOUNDATION, OUR AIM IS TO DRIVE INDUSTRY IMPROVEMENT. WE PLAN FOR THE CONFERENCE TO KEEP DEVELOPING IN THE YEARS TO COME AS AN IMPORTANT MEANS OF ACHIEVING THAT END.”
Mike Etherington-Smith, equine safety advisor, and Francesca Compostella, aftercare lead, explored racing’s aftercare responsibility towards its equine athletes.
A number of horse welfare projects were also discussed, including the Racing Foundation-funded Orange to White project.
Currently being phased into British racing, the Orange to White project has seen an estimated 368 fences and 2,132 hurdle panels across 40 racecourses change markings from the traditional orange to white.
The project, which Etherington-Smith and Compostella explained as being delivered by the Horse Welfare Board as part of the ‘Life Well Lived’ strategy, followed intensive research carried out by Exeter University into equine vision between 2017 and 2018.
The study found that changing the wood and vinyl padding of take-off boards, guard rails and top boards to white provided increased contrast and visibility for horses, leading to improved jumping performance.
Rhi Lee-Jones, communications and events manager for the Racing Foundation, said: “The 2022 Horseracing Industry Conference was the biggest yet with 227 tickets allocated.
“I’d like to thank our speakers and panel experts for delivering such thoughtful and challenging dialogue and contributing to insightful debate, which I hope engaged and ignited action in our delegates.
“At the Racing Foundation, our aim is to drive industry improvement. We plan for the conference to keep developing in the years to come as an important means of achieving that end.
“That process of alignment and coordination is crucial, and it needs to be informed by racing’s leaders. They need to be visible and articulate the direction of travel but also be prepared to listen, reflect and respond to what they hear.
“I would like to reiterate our thanks to all those who attended.”
Horseracing and Thoroughbred Industries MBA graduate Katie Walker also presented her research on the effect of whip use on stride parameters of the racehorse—more details of which can be found on page 55.
Conference delegates heard an analysis on the impact of equality, diversity and inclusion (ED&I) in British racing in a talk that explored whether it was making progress in British racing or was merely ticking boxes.


The final keynote address of the day came from Sustainability Consultant Ruth Dancer, who has recently completed a scoping exercise into British racing’s environmental sustainability practices. The White Griffing consultant examined with delegates the findings of the recently published report, looking into the way in which environmental sustainability impacts the British horse racing industry. From water shortages to the potential for biodiversity, Dancer detailed the risks, challenges and opportunities for the sport in this area. The importance of a whole industry approach was emphasised along with how horse racing might move towards Britain’s net zero goal on carbon emissions by 2050. Social licence was again mentioned and was a common theme throughout the day, with Dancer highlighting the importance of environmental sustainability for the next generation. The carbon footprint of delegates’ travel to the conference was also offset by the Racing Foundation through the process of carbon sequestration, reinforcing the Foundation’s commitment to environmental sustainability and its belief that the issue has to be at the heart of not only racing’s future, but its present too.
To conclude the 2022 conference, racing’s leaders formed a leadership panel in which they took questions from attending delegates. Among the leadership panel was Chief Executive of the National Trainers Federation Paul Johnson, Chief Executive of the Thoroughbred Breeders’ Association Claire Sheppard, and Chief Executive of the Racecourse Association David Armstrong. Chief Executive of the Racehorse Owners Association Charlie

Liverton and Tim Naylor, the director of Integrity and Regulation for the British Horseracing authority, completed the expert panel.
Neil Coster, director of studies for the Thoroughbred Horseracing Industries MBA at University of Liverpool Management School, said: “It has been fantastic to see the conference evolve since it started in 2018—more than doubling in size and this year attracting a record number of delegates.

“The University is delighted the event continues to showcase the graduates’ research projects, and this highlights one of the philosophies of the conference—that of better informed decision making. It is now seven years since the launch of the MBA, and we are pleased to see a number of our graduates progressing to senior positions in the industry.”
To be the first to hear about the 2023 Horseracing Industry Conference, sign up to the Racing Foundation newsletter at www.racingfoundation.co.uk/news
IT HAS BEEN FANTASTIC TO SEE THE CONFERENCE EVOLVE SINCE IT STARTED IN 2018, MORE THAN DOUBLING IN SIZE AND THIS YEAR ATTRACTING A RECORD NUMBER OF DELEGATES.”ABOVE: The leadership panel (l-r) David Armstrong, Charlie Liverton, Claire Sheppard, Tim Naylor and Paul Johnson.
Katie Walker, a recent graduate of the Thoroughbred and Horseracing Industries MBA, presented her research project findings regarding the effect of the whip at the 2022 Horseracing Industry Conference. The project explored how sectional time/stride data could be used to analyse the impact of the whip in the closing stages of races. The project, supported by the HBLB, made use of the data provided by Total Performance Data to determine what insights could be gained regarding both the performance and health of equine athletes. The use of the whip is a prevalent topic in British horse racing, with the British Horseracing Authority’s Whip Consultation Report released in July 2022 recommending research into “the effects of the whip, using any relevant scientific advances to inform policy.”

For this study, data was collected from two match sets: hands and heels races and whip permitted races. Both sets were drawn from races post2017, when stride data became available; and a limiting factor must be noted regarding the small quantity of hands and heels races, and therefore, data available.
Stride length and stride frequency in the final three furlongs of each race were extracted, controlling for trip, ground, number of runners, quality of horse and racecourse as far as possible. No significant difference in stride frequency was found; however, a small but significant difference in stride length was found, with horses in whip permitted races having marginally longer strides. This was recorded as follows. 3f – 2f = 0.09m, 2f – 1f = 0.12m and 1f to finish = 0.05m. However, the reasons that trainers run horses in hands and heels races may lead to selection bias, which makes further analysis necessary.
This analysis was performed with both sets of data. In the final three furlongs, it was found that the stride length of whip permitted horses decreased by 0.4m (5.7%), whereas hands and heels horses’ stride length decreased by 0.36m (5.2%).
Horses placed 1st, 2nd and 3rd in all races were then subtracted to find the stride length declines in the final three furlongs, hence disregarding the horses out of contention. Data showed a similar pattern of a reduced

decrease in stride length for horses in hands and heels races. Hence as the table below shows, horses in races with the whip permitted show a larger decrease than hands and heels-ridden horses—a surprising finding.
No firm conclusions can be made here due to the limitations of the data, but it raises the question of the impact of the whip. The use of stride parameters per second, as opposed to averages over a furlong, and adding whip counts, could produce studies where hands and heels races are not required for analysis. This would allow for a larger data set and more detailed analysis.
Sensors on the whip could count both the strikes and the force to give an enhanced picture of how the horse is responding and performing, bringing into focus how jockey training would also be influential on these factors. Cardiac monitoring is advised for this deeper analysis to monitor for signs of distress in the horse. Interference between participants is a major safety concern during the running of a race and could be monitored with use of this data and guide future rule reviews. In short, funding for this analysis could be revolutionary in a range of welfare and integrity concerns.



Most experienced trainers will know from bitter experience that a seemingly tiny wound can have a big impact if a horse is unlucky enough to sustain a penetrating injury right over a critical structure like a joint capsule or tendon sheath. Collectively, joints and tendon sheaths are called synovial structures, and synovial infection is a serious, potentially career-ending and sometimes life-threatening problem.
A team of veterinary researchers from Liverpool University Veterinary School published a study in Equine Veterinary Journal that examined factors influencing outcome and survival. This article was first published in European Trainer (issue 50 - summer 2015) but is being republished due to popular demand.
ABOVE: Looking inside joints and tendon sheaths allows the identification of any foreign material such as dirt or hairs or damage to internal structures such as a cut to a tendon.


Infection involving a synovial cavity, such as a joint or tendon sheath, is a common and potentially serious injury for the horse. The most prevalent cause is a wound, although a smaller proportion of cases result following an injection into a joint or tendon sheath, or after elective orthopaedic surgery to the area. Additionally, infection can occur via the bloodstream, particularly in foals that have not received enough colostrum. Left untreated, the horse will remain in pain, and ongoing infection and inflammation can result in permanent damage. This can ultimately result in euthanasia on welfare grounds.

When a synovial infection occurs, there is a huge inflammatory response, leading to swelling and pain. The horse usually shows severe lameness but following a good clinical examination, the cause is often quickly identified. Prompt veterinary recognition of involvement of a joint or tendon sheath and aggressive treatment (involving flushing the affected synovial cavity and the correct use of systemic and local antibiotics) will often result in a good outcome for the horse. Flushing removes inflammatory debris including destructive enzymes and free radicals, and it eliminates contaminating bacteria in most cases. This is performed most effectively by arthroscopic guidance (“keyhole” surgery) under general anaesthesia. Using a “scope” to do this is considered superior to flushing through needles because arthroscopy allows the inside of the problem area to be inspected, foreign material (for example, dirt or splinters of wood) to be removed, and any concurrent damage (such as damage to the cartilage or a cut into a tendon) to be evaluated. In addition, targeted high volume lavage is best achieved via arthroscopy.
LEFT : Wounds are a common cause of synovial infection: here an overreach injury at the back of the fetlock area has caused an infection into the tendon sheath.
Survival following arthroscopic treatment of synovial sepsis is good – approximately 80-90% of adult horses undergoing a flush are discharged from hospital. In foals, however, the figure is much lower, at around 55%, and this is likely due to complicating factors such as concurrent sepsis involving multiple organs. Our study, recently published in Equine Veterinary Journal, investigated what factors might be involved in determining survival to hospital discharge in 214 horses undergoing arthroscopic treatment for synovial sepsis. We used statistical modelling to evaluate the interactions with different factors at three key time points during the management of the condition at Liverpool Veterinary School, one of the leading UK referral veterinary hospitals. Information collected on admission to the hospital included when the horse was last seen to be normal, the cause of the infection, the degree of lameness present, and the level of white blood cells and protein in synovial fluid collected from the infected joint or tendon sheath. These lab tests are an important method which veterinarians use to determine how severe the infection is. Additional data collected included whether the surgery was performed out-of-normal working hours, if foreign material was present, the amount of inflammation present in the area, and whether any additional cartilage or tendon damage was found at surgery. Post-operative information gathered included what the levels of white blood cells and protein were in the synovial fluid after surgery and whether the horse needed further surgical treatment.
All horses in this study were greater than six months old and the majority had sustained a wound that communicated with a joint or tendon sheath. Eighty-six per cent of the 214 horses admitted to the hospital survived to hospital discharge. Of the 31 horses that did not survive, 27 were euthanised due to persistent infection or lameness.
A high level of protein in the synovial fluid of the affected joint or tendon sheath on admission and levels that remained high after surgery were strongly associated with a poor outcome and loss of the horse. Protein concentrations are normally fairly low in a normal joint or tendon sheath, but protein leaks into the synovial cavity from surrounding blood vessels when inflamed. Protein is also produced by cells in the synovial cavity when they are activated in response to a severe insult such as infection. Protein clots trap bacteria in the joint, making it harder to remove infection. The protein soup also includes lots of inflammatory mediators such as enzymes and signalling molecules, and these cause further inflammation, tissue damage, and sensitise pain receptors in the synovial cavity magnifying the inflammatory response and increasing the pain experienced by the horse. Unchecked, this angry, inflamed environment can result in cartilage degeneration, bone damage, and adhesion (scar) formation. This fits well with another observation from this study linking the presence of moderate or severe synovial inflammation at surgery as a negative factor for survival.
Interestingly, horses presenting with an obvious wound (as opposed to a small penetrating injury or no visible wound) were more likely to survive to hospital discharge. This may be due to the injury being noticed earlier and hence prompting earlier veterinary intervention. Alternatively, open wounds may allow drainage of inflammatory synovial fluid and lessen the detrimental effects of increased pressure within the joint as well as reducing ongoing exposure to inflammatory mediators. This finding highlights the fact that trainers should act promptly when faced with a wound. It is easy to underestimate just how much damage may be going on under the surface.
Horses undergoing surgical treatment of a joint or tendon sheath infection out-of-hours (for example in the middle of the night) were three times less likely to survive to hospital. Often, horses with a synovial infection arrive stressed and painful and not in an ideal state for having an anaesthetic. Early identification of an infection and appropriate management are important, but stabilisation of the horse and preparation for surgery appear to outweigh any perceived benefits of undertaking immediate surgery. This is borne out by the finding that time from initial injury to treatment was not associated with outcome and is in agreement with previous findings from other researchers. It is important to reiterate that prompt recognition and treatment of a horse with an infection in a synovial cavity is essential but that surgical management within 12-24 hours of diagnosis, so that the horse is in the best condition for undergoing anaesthesia, does not affect outcome.
The big question that owners and trainers want to know is whether the horse will regain full function of the joint or tendon sheath after having an infection. Figures for return to function following surgical (arthroscopic) treatment for a synovial infection vary between 54-81%. Various factors appear to relate to outcome but when looking at a predominately thoroughbred racing population, the statistic for return to training appears to be at the higher end of this range. Factors associated with failure to return to athletic performance include the presence of thickened inflammatory tissue (known as pannus) at the time of surgery and that may relate to the development of fibrous adhesions and scar tissue within joint or tendon sheath longer-term. Some structures are particularly likely to compromise future function, and horses with an infection of the navicular bursa in the foot following a nail penetration generally do worse.
Horses sustaining an infection to a joint or tendon sheath have a good chance of the infection clearing up and surviving the injury, with the likelihood of racing as high as around 80%. Our key message for trainers from this study is that it is essential that they recognise early when an infection involves one of these structures and have a veterinarian fully evaluate the injury. Aggressive treatment is important and involves flushing the synovial cavity using a “scope” under anaesthesia to remove as much inflammatory and infective debris as possible.



Think of racing in Switzerland, and the fabulous White Turf meeting on Lake St. Moritz probably comes to mind. This is no surprise, of course. The EMHF was fortunate to hold its General Assembly there in 2015, and for many of our delegates, including your columnist, it remains among the most memorable racing adventures of all. But there is so much more to racing in that country.
Sadly, St Moritz’s little sister track, which provided racing on the frozen lake at Arosa, is no longer with us. Weather conditions in recent years meant that there had become a worse than even-money chance of abandonment—a situation that was just not financially sustainable.
But the full roster of Swiss thoroughbred tracks still extends to seven. (Although one of the tracks, at Fehraltorf, which had upheld a 75-year tradition of racing over the Easter holiday, remains in a state of hiatus following an altercation last year with a neighbour farmer, who took the dramatic and disruptive decision to plough up the racing surface.)

Jump racing is the primary focus at Aarau and Maienfeld, while the flat dominates at Zurich-Dielsdorf,

Frauenfeld (home of the Swiss Derby) and at the track that is the financial powerhouse of Swiss racing, Avenches. This August saw celebrations for the 150th year of the Zurich race club, which coincided with 50 years of its current racecourse, at the small nearby town of Dielsdorf. A two-day festival was crafted, during which the 1500-metre, pancake-flat turf track staged 14 races: nine thoroughbred flat, two trotting and three pony. This left-hand track also boasts a jump course, but this is used infrequently these days.
Interwoven with the races, there was an appearance of the 250-year-old Bernese Dragoons, a mesmeric display from world-renowned Jean-Francois Pignon’s ‘free dressage’ horses, after-racing musical acts and, notably, a parade of former equine stars of Swiss racing showing off their expertise in new-found careers. Aftercare has long been a feature of Swiss racing. Horses tend to stay in training for longer than the norm on the flat, allowing the public to build up the kind of rapport with them normally associated with jump racing. In addition, they tend to race more frequently than in most countries, averaging nearly eight starts annually and this helps to buoy field sizes and makes for attractive, competitive racing generally.
LEFT: Frauenfeld – home of the Swiss Derby.

RIGHT: Swiss racing's financial powerhouse – Avenches.
The substantial crowds were engaged and relaxed, and it all made for a wonderfully rewarding racing experience.
When it comes to funding, Swiss racing is swimming against the tide, in many ways akin to the experience in Belgium, described in the last issue of Trainer. This is because, with one principal exception, there is no opportunity for people within or outside the country to place bets on Swiss races unless they are on-track. The twin State-installed institutions (one French-language, the other German), which between them enjoy a betting monopoly, decline to include domestic racing within their product mix. The exception is Avenches, where the bulk of the races has been taken on by the French betting giant PMU, are shown on the Equidia channel, and are available to Swiss and French citizens to bet on, in cafes, bars and kiosks and online. (In 2022, a few PMU races were also held in Frauenfeld and Dielsdorf). The commission from this betting activity is vital to Avenches and also helps support Swiss racing generally, but the other Swiss tracks rely critically on donations and sponsor contributions.
Unsurprisingly, the scale of the industry has suffered a worrying contraction. What had been a slow but steady reduction in the numbers of owners, horses, races and prize money between 2015 and 2019 accelerated dramatically in the COVID year of 2020. Over the past seven years, prize money has halved, and the numbers of horses and owners have reduced by 51 percent and 48 percent, respectively.

The Swiss race programme is heavily weighted towards staying races. While Handicaps are out of bounds to foreign-trained runners, they only constitute a modest proportion of the race programme and all conditions races are open. Average prize money per race remains very respectable, at nearly €10,000. The Grand Prix von St Moritz is, at €100K, clearly the nation’s richest race. Other significant prizes include the Grand Prix d’Avenches (€20k for 3yo+, weight-for-ages, 2400m/12f), Zurich’s Grand Prix Jockey Club (€50k for 3yo+, weight-for-age, 2475m/12f+), and the Swiss Derby (€50K). The country’s main jump race is the €35K Grand Prix of Switzerland, run over (4200m/21f) in beautiful surroundings at Aarau in September with a limited weight range of just 3kgs.
For five years, between 2014 and 2018, both the Grand Prix d’Avenches and the Grand Prix Jockey Club boasted Black Type. Regrettably, neither managed to maintain the strict ratings threshold required of such races in Europe. Fresh hope has been generated by the new scheme, agreed this year, whereby EMHF member countries without a Black Type race can apply for such recognition for a single, flagship event which is allowed a rating 5lbs lower than normal. There is a real desire that one or another of these races can clear this lowered bar but, as is normally the case, this is likely to hinge on their attracting foreign-trained runners rated 95+ on the international scale. And, considering
the decent prizes, foreign-trained runners are relatively thin on the ground, accounting for under five percent of starters. British and German raiders are attracted to the snow, Czech runners to some of the jumps races, but foreign runners on the flat have been in single figures over the past two years.
There was, in fact, a third milestone included within the Zurich celebrations: the tenth anniversary of Horse Park Dielsdorf. The Horse Park brings together the racing and equestrian worlds in a way which could surely be gainfully replicated in many more parts of Europe. Alongside the racetrack and training barns housing 150 horses, there are FEI-standard facilities for show jumping and dressage. A recent addition, completed within the past year, is a large stylish building which, in its restaurant configuration, comfortably seats 250 with a fine view of the racing. Various facilities around the complex are available year-round to the general public for hire. In investing some €8M into this project, Race Club President Anton Kraeuliger has demonstrated both a recognition of the importance of sweating the asset that is the racecourse and an enduring belief in Swiss racing. Let us hope that this confidence is well-placed and that racing in this most beautiful of European countries can look forward to a thriving future.
Those in charge of pony racing travelled to Budapest from all over Europe to attend the inaugural annual meeting of the European Pony Racing Association (EPRA) on September 11th. Representatives from Belgium, Czech Republic, France, Great Britain, Hungary, Norway, Slovakia and Sweden had, the previous day, witnessed three pony races that kick-started the quality thoroughbred card at Hungary’s sole track, Kincsem Park. They were universally impressed at the professionalism of the pony racing, the hospitality and the great strides which Kincsem Park has made in recent years. It is a very different racecourse from the one that hosted an early EMHF meeting in 2013 and as striking an example of diversity as one can find. Today, every square metre of the track’s footprint is put to productive use. In addition to the flagship thoroughbred racing, there is greyhound racing, trotting, a training centre, show jumping, four-in-hand driving and more. There is even a rugby pitch inside the greyhound track!
Increased internationalisation of pony racing, with the best young riders having the opportunity to experience race-riding in other countries, is an aim of the EPRA, and it was pleasing to witness history being made. Czech youngster Sophy Bodlakova became the first foreign-based winner of a Hungarian pony race when she scored on her pony Saman!

While for some EPRA member countries, such as France, Sweden and Britain, pony racing is a well-established pursuit; for some, it is a very new endeavour, and for others yet, it is something to be established in the near future. The imparting of knowledge and identification of best practice will therefore be central to the fledgling association.
Slovakia’s experience bears witness to the fact that countries need not wait for long, after setting up a pony racing structure, to see the benefits begin to flow, in the shape of new jockeys. It was only last year that the first pony races took place at Bratislava

racetrack, but from the alumni of that first cohort, there are this year no fewer than four amateur riders licence-holders. For those many countries experiencing difficulties in sourcing competent race riders, a pony racing structure is a must-have.
At the EPRA meeting, a minute’s silence was observed in honour of Jack de Bromhead, who tragically lost his life in a pony racing incident in Ireland.
For many delegates, it was the first experience of pony racing outside their own countries. Next year, the EPRA has accepted a kind invitation from France to host.
Botond Kovacs, head of pony racing in this year’s host country, commented: “We have been thrilled to host the first European Pony Racing Association meeting. The rise in profile of pony racing is very refreshing to see. The European Pony Racing community is taking shape and it feels like we’ve been put on the map—a map that the world of racing has a keen eye on.”

There will be a spanking new venue for official beach racing in Spain this year when the Andalucian village of Zahara de los Atunes opens its doors to thoroughbred racing on Saturday, October 29th— the middle day of an attraction-packed three-day beach festival, bookended by jazz concerts and polo. Long known for its beachbar music scene, horseracing will now be used in Zahara in an attempt to prolong the tourist season in this southernmost part of Spain until the end of October.
The Costa de la Luz now boasts two beach tracks, with the venerable Sanlucar de Barrameda an hour-and-a-half drive up the coast. Zahara’s stunning straight beach will accommodate races between 1400m/7f and 1800m/9f.

Plans for the Zahara festival were unveiled at this year’s annual meeting of the European Beach Racing Association, which took place in Cuxhaven, on Germany’s north seacoast. Delegates had been privileged to witness the famed Duhner-Wattrennen races, which have been staged on the vast beach for the past 120 years. An attentive and happy paying crowd of 13,000 attended this year’s renewal, despite poor weather. The programme was varied, with trotting (mounted and sulky) and gallop races for warmbloods in addition to thoroughbred racing.
Cuxhaven is unique among beach racetracks in that the horses race through a shallow covering of standing water. The resultant spray, from the horses’ hooves and the wheels of the patrol vehicle, creates its own spectacle. The races are recognised as a powerful tourist attraction—a national minister attended and addressed the launch party before proceedings began.


Zahara is but a stone’s throw from Morocco, and three weeks after its fledgling festival, Casablanca will host the latest of its well-established and handsomely endowed International Thoroughbred Race Days.

Entries for the four races, which are run on Saturday the 19th of November, close at the end of October.
Headlining is the €110,200 Grand Prix de la SOREC, one of the international Defi du Galop series of events, run over 2400m/12f for 3yo’s and up. The support card comprises a 1750m/8.75f event for 3yo fillies (€64,300), a race for the 3yo colts over 1900m/9.5f (€55,100) and a 1750m/8.75f for the staying 2yo (€25,700). All races are run on the dirt track. Entry fees are around one percent of the race fund.
SOREC (the Moroccan racing authority) is eager to see the festival get fresh impetus after the sad interruption due to COVID. Keen to encourage international participation, it will be putting on a plane to transport runners from a central European location (exact departure point to be determined), awarding travel
allowances of up to €3,000 per horse, meeting the costs of flights and accommodation for the owner, trainer and jockey and hosting a gala dinner. Stable staff will be put up at the nearby training centre, where the visiting horses will be stabled.
“Since 2015,” explains Hicham Debbagh, SOREC’s deputy general manager in charge of horse racing, “our objective was to install the Morocco International Meeting in the international calendar, through attractive prize money and free air transport, in order to guarantee the best reception conditions for horses and professionals. Prior to COVID, things were progressing nicely, and we were attracting good horses from England, France, Libya, Netherlands, Oman, Poland, Qatar, Spain, Syria and UAE. Now that travel has opened up again, we look forward to building our festival back up as an international destination. Welcome to Morocco!”

Anfa Racecourse is an oasis of calm and beauty in the sprawling metropolis that is Casablanca. Trainers might well consider a Moroccan raid. Prize money extends down to fifth place, and the average field size for the four races in (pre-COVID) 2019 was 11. At the same time, it provides connections with the chance to experience racing in a nearby country with a fascinatingly distinct culture, and it will be helping inject the necessary quality of the runners to enable Morocco to achieve its dream of acquiring its first Black Type race.





“I’ve been using Connolly’s RED MILLS for some time now, my horses look and feel great. They’re eating and working well and recovering quickly after running. It’s great to have the support of their team which means a lot.”







Winner of the GOFFS Million Trainer Charlie Hills Jockey Shane Foley Owner Aura (Gas) Holdings Ltd

CHARLIE HILLS, TrainerGaleron and Shane Foley winning the Goffs Million at The Curragh